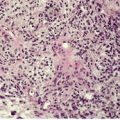

Introduction398
INTRODUCTION
The normal hair follicle
INFLAMMATORY DISEASES OF THE PILOSEBACEOUS APPARATUS
ACNEIFORM LESIONS
ACNE VULGARIS
Etiology and pathogenesis
Treatment of acne vulgaris
Histopathology15. and 169.

Fig. 15.1

Fig. 15.2
Electron microscopy
ACNE FULMINANS
Histopathology196
CHLORACNE
Histopathology197. and 201.
SUPERFICIAL FOLLICULITIDES
ACUTE SUPERFICIAL FOLLICULITIS
Histopathology
ACTINIC FOLLICULITIS
ACNE NECROTICA
Histopathology214

Fig. 15.3
NECROTIZING FOLLICULITIS OF AIDS
Histopathology
EOSINOPHILIC (PUSTULAR) FOLLICULITIS
Treatment of eosinophilic pustular folliculitis
Histopathology223.224.229. and 263.
INFUNDIBULOFOLLICULITIS
DEEP INFECTIOUS FOLLICULITIDES

Fig. 15.4
FURUNCLE
Histopathology308
PSEUDOMONAS FOLLICULITIS
Histopathology309


Fig. 15.5
OTHER BACTERIAL FOLLICULITIDES
Histopathology
VIRAL FOLLICULITIS
Histopathology
Viral-associated trichodysplasia
Histopathology

Fig. 15.6
DERMATOPHYTE FOLLICULITIS
Histopathology
PITYROSPORUM FOLLICULITIS
DEEP SCARRING FOLLICULITIDES
FOLLICULITIS DECALVANS
Histopathology205. and 343.

Fig. 15.7
FOLLICULITIS KELOIDALIS NUCHAE
Histopathology353. and 354.


Fig. 15.8
FOLLICULAR OCCLUSION TRIAD
ACNE INVERSA (HIDRADENITIS SUPPURATIVA)
Treatment of acne inversa (hidradenitis suppurativa)
Histopathology435


Fig. 15.9
DISSECTING CELLULITIS OF THE SCALP
Histopathology458
ACNE CONGLOBATA
Histopathology
MISCELLANEOUS FOLLICULITIDES
PSEUDOFOLLICULITIS
Histopathology472
PRURITIC FOLLICULITIS OF PREGNANCY
PERFORATING FOLLICULITIS
Histopathology205. and 486.

Fig. 15.10
FOLLICULAR TOXIC PUSTULODERMA
STERILE NEUTROPHILIC FOLLICULITIS WITH PERIFOLLICULAR VASCULOPATHY
Histopathology
PSEUDOLYMPHOMATOUS FOLLICULITIS
Histopathology499
HAIR SHAFT ABNORMALITIES
FRACTURES OF HAIR SHAFTS
TRICHORRHEXIS NODOSA
Histopathology

Fig. 15.11
TRICHOSCHISIS
Histopathology

Fig. 15.12
TRICHOCLASIS
TRICHORRHEXIS INVAGINATA
Histopathology
TAPERED FRACTURES
TRICHOPTILOSIS
TRICHOTEIROMANIA
TRICHOTEMNOMANIA
IRREGULARITIES OF HAIR SHAFTS
PILI CANALICULATI ET TRIANGULI
Histopathology
Electron microscopy
PILI BIFURCATI
PILI MULTIGEMINI
TRICHOSTASIS SPINULOSA
Histopathology575
PILI ANNULATI
Histopathology
MONILETHRIX
Histopathology

Fig. 15.13
TAPERED HAIRS
BUBBLE HAIR
TRICHOMEGALY
COILING AND TWISTING ABNORMALITIES
PILI TORTI
Histopathology

Fig. 15.14
WOOLLY HAIR
Histopathology
ACQUIRED PROGRESSIVE KINKING
CURLY HAIR
TRICHONODOSIS
CIRCLE AND ROLLED HAIR
Histopathology
EXTRANEOUS MATTER ON HAIR SHAFTS
TINEA CAPITIS
PIEDRA
Histopathology
TRICHOMYCOSIS AXILLARIS


Fig. 15.15
PEDICULOSIS CAPITIS
Histopathology
HAIR CASTS
Histopathology679. and 681.
ALOPECIAS
Infundibular level
Lichenoid reaction (interfollicular epidermis)
Lymphocytic infiltrate ± fibrosis
Neutrophilic infiltrate ± fibrosis (also lymphocytes and plasma cells)
Miniature hair shafts
Androgenetic alopecia
Melanin casts
Trichotillomania/traumatic alopecia
Isthmus level
Lymphocytic infiltrate ± fibrosis
Miniature bulbs and follicles of varying diameter (non-inflamed)
Miniature bulbs (inflamed ± apoptosis)
Melanin casts/trichomalacia
Trichotillomania/traumatic alopecia
Hair bulb level
Fibrous tract and reduced number of follicles
Alopecia areata
Lupus erythematosus } also pigment incontinence
Lichen planus
Inflamed hair bulbs (‘swarm of bees’)
Active alopecia areata
‘Torn’ catagen follicles ± hemorrhage
Trichotillomania/traumatic alopecia
The normal hair cycle

Fig. 15.16

Fig. 15.17
CONGENITAL/HEREDITARY ALOPECIAS
ALOPECIA UNIVERSALIS CONGENITA
Histopathology
HEREDITARY HYPOTRICHOSIS
Histopathology
ATRICHIA WITH PAPULAR LESIONS
Histopathology763
KERATOSIS PILARIS ATROPHICANS
HALLERMANN–STREIFF SYNDROME
Histopathology
SHORT ANAGEN SYNDROME
PREMATURE CATAGEN/TELOGEN
TRICHOTILLOMANIA AND TRAUMATIC ALOPECIA
Histopathology685.807.808.809.810. and 811.

Fig. 15.18
TELOGEN EFFLUVIUM
Histopathology
PREMATURE TELOGEN WITH ANAGEN ARREST
ALOPECIA AREATA
Pathogenesis
Treatment of alopecia areata
Histopathology942


Fig. 15.19

Fig. 15.20
Electron microscopy975
VELLUS FOLLICLE FORMATION
ANDROGENETIC ALOPECIA
Treatment of androgenetic alopecia
Histopathology1038. and 1039.

Fig. 15.21
TEMPORAL TRIANGULAR ALOPECIA
Histopathology
ANAGEN DEFLUVIUM
LOOSE ANAGEN SYNDROME
Histopathology
DRUG-INDUCED ALOPECIA
Histopathology
SCARRING ALOPECIAS
Different approaches to scarring alopecias
Folliculitis decalvans
Tufted folliculitis
Erosive pustular dermatosis of the scalp
Acne keloidalis nuchae
Dissecting cellulitis of the scalp
Kerion
Traction alopecia
Classification of cicatricial alopecias by inflammatory infiltrate
IDIOPATHIC SCARRING ALOPECIA (PSEUDOPELADE)
Histopathology683. and 971.

Fig. 15.22
TRACTION ALOPECIA WITH SCARRING
Histopathology
POSTMENOPAUSAL FRONTAL FIBROSING ALOPECIA
FIBROSING ALOPECIA IN A PATTERN DISTRIBUTION
FOLLICULITIS DECALVANS
TUFTED-HAIR FOLLICULITIS
MISCELLANEOUS ALOPECIAS
LIPEDEMATOUS ALOPECIA
Histopathology

Fig. 15.23
MISCELLANEOUS DISORDERS
PILOSEBACEOUS DISORDERS
The normal sebaceous gland
Miscellaneous disorders of the pilosebaceous unit
HYPERTRICHOSIS
Congenital hypertrichosis lanuginosa
Acquired hypertrichosis lanuginosa
Congenital circumscribed hypertrichosis1171
Acquired circumscribed hypertrichosis1171
Histopathology
KERATOSIS PILARIS
Histopathology

Fig. 15.24
KERATOSIS PILARIS ATROPHICANS
Keratosis pilaris atrophicans faciei (ulerythema ophryogenes)
Keratosis follicularis spinulosa decalvans
Atrophoderma vermiculata
Histopathology
FOLLICULAR SPICULES
LICHEN SPINULOSUS
Histopathology1298
PITYRIASIS FOLLICULORUM
ROSACEA
Treatment of rosacea
Histopathology1396

Fig. 15.25

Fig. 15.26

Fig. 15.27
PYODERMA FACIALE (ROSACEA FULMINANS)
Histopathology1407
SQUAMOUS METAPLASIA OF SEBACEOUS GLANDS
NEUTROPHILIC SEBACEOUS ADENITIS
FOLLICULAR SEBACEOUS CASTS
APOCRINE DISORDERS
The normal apocrine gland
![]()
Stay updated, free articles. Join our Telegram channel

Full access? Get Clinical Tree



Diseases of cutaneous appendages
INFLAMMATORY DISEASES OF THE PILOSEBACEOUS APPARATUS399
HAIR SHAFT ABNORMALITIES411
ALOPECIAS417
MISCELLANEOUS DISORDERS431
This chapter covers the non-tumorous disorders of the cutaneous appendages, the great majority of which are inflammatory diseases of the pilosebaceous apparatus. Inflammation of the apocrine and eccrine glands is quite uncommon by comparison. Hamartomas and some related congenital malformations are included with the appendageal tumors in Chapter 33 (pp. 779–781).
The following categories of appendageal diseases will be considered in this chapter:
• inflammatory diseases of the pilosebaceous apparatus
• hair shaft abnormalities
• alopecias
• miscellaneous disorders.
Before considering these diseases, a brief account will be given of the normal hair follicle. As the changes that occur during the hair cycle are relevant to the alopecias, this aspect is discussed on page 418.
Hair follicles are derived from the fetal epidermis as a downward-projecting epithelial bud, which is guided in its subsequent development by an accumulation of mesenchymal cells in the underlying dermis – the dermal papilla. 1 This process is under the control of various substances, one of which is the mesenchymal cell membrane protein known as epimorphin. 2
Hair follicles are found in a variably dense population throughout the body, except for palmar-plantar skin. The follicle and its attached sebaceous gland and arrector pili muscle form a structural unit. In some parts of the body (axilla and genitocrural region) an apocrine gland is connected to the upper part of the sebaceous duct. Hair follicles produce a hair shaft, which arises from the deep portion of the follicle. Two distinct types of hair shaft are recognized: terminal hair, a heavily pigmented, thick shaft arising from a terminal hair follicle, which projects into the deep dermis and even into the subcutis; and vellus hair, a short, fine, lightly pigmented shaft which arises from a vellus hair follicle; it only extends into the upper reticular dermis. Both types of hair follicle go through a life cycle (see p. 418) but the length of the anagen phase is much shorter in vellus hair follicles. 3
The hair follicle is divided into four anatomical regions – the infundibulum, the isthmus, the suprabulbar zone, and the hair bulb. The infundibulum extends from the skin surface to the point of entry of the sebaceous duct. Its lining cells show epidermal keratinization. Below this is the isthmus, the short portion between the entry of the sebaceous duct and the attachment of the arrector pili muscle. This region contains two important structures, the bulge region and the follicular trochanter. 4 The bulge region, which contains follicular stem cells and stains with CK19, CK15, and CD200, is a region of the outer root sheath at the point of insertion of the arrector pili muscle. Another bulge in the outer root sheath in this same region has been called the follicular trochanter. Little is known of its function. 4 Some follicular stem cells are present in plucked hair, presumably from this region. 5 Between the isthmus and the hair bulb is the suprabulbar region. The bulb is the expanded lower end of the follicle which includes the dermal papilla; it is surrounded on its top and sides by the hair matrix, the part of the bulb which is the actively growing portion of the hair shaft.
The terminal hair shaft is composed of three layers – the medulla, the cortex, and the inner root sheath. The medulla forms the central core of the hair shaft. It is not present in all human hairs, although it is an important structure of some animal hairs, such as wool. 3 The size and form of the medulla, at least in scalp hair, is regulated by the stage of the hair cycle and by the cross-sectional size of the hair shaft. 6 The cortex constitutes the bulk of the hair. It is composed of densely packed keratins, both epithelial keratins and keratins unique to ‘hard’ structures such as nails and hairs. There are 17 hair keratins. Like epithelial keratins, they are grouped into type I (acidic) and type II (neutral-basic) hair keratins. There are 11 type I hair keratins and six type II hair keratins. 7 Under the new consensus nomenclature for mammalian keratins there has been a change to the names of some of the keratins and to the gene designations. 8 Gene names are preceded by KRT. The type I hair keratins have been designated K31–40 (there is a 33a and 33b), while the type II hair keratins have been designated K81–86. 8 As all papers in the dermatological literature referred to in this chapter have used the old Moll system, it will be followed here, although gene nomenclature has largely been updated.
The hair cortex is covered by a single row of overlapping cells, the shaft cuticle. External to the shaft cuticle are the three layers forming the inner (internal) root sheath – an inner sheath cuticle (which intermeshes with the shaft cuticle), Huxley’s layer, and an outer Henle’s layer, which keratinizes first. The three layers blend together with keratinization and are no longer distinct by the mid-follicle. Keratinization occurs through the formation of trichohyaline granules. Outside the inner root sheath is the outer (external) root sheath. It is composed of clear cells, rich in glycogen. It is only one cell thick at the level of the bulb; it is thickest at the isthmus, where it starts to keratinize, forming a narrow zone of tricholemmal keratinization. The single-cell inner layer of the outer root sheath undergoes specialized keratinization mediated by apoptosis. 9 Above the isthmus, the cells assume epidermal characteristics and line the infundibulum. Enclosing the hair follicle is a vitreous (‘glassy’) layer, which is PAS positive. It becomes thickened and wrinkled during catagen. Beyond this is the fibrous root sheath, which is continuous below with the follicular papilla; it blends above with the collagen of the papillary dermis. CD10 is strongly expressed in the perifollicular dermal sheath. 10
The adult hair follicle contains the following keratins: the basal layer keratinocytes of the infundibulum express K5/6 and 14, whereas those in the suprabasal layer show K1, 4, 10, and 14, similar to adult epidermis. The keratinocytes of the isthmus show K5/6, 14, 17, and 19. The cells of the inner root sheath stain for K4 and 18. All stain for involucrin, including the matrical cells which stain for nothing else. 11 These keratin designations have not been updated using the 2006 consensus nomenclature for mammalian keratins. 8
The arrector pili muscle attaches to the pilosebaceous apparatus, via elastic tendons, at the bulge area. Some muscle fibers can be found admixed with the connective tissue sheath encircling the follicle. The anchor between the distal arrector pili and the extracellular matrix includes both α5β1 integrin and fibronectin.12. and 13.
Attention has turned recently to the hair follicle immune system and its possible role in the causation of alopecia areata and the folliculitides that are a common problem in immunocompromised persons. The distal part of the human hair follicle appears to represent a specialized area of the skin immune system with interacting intraepithelial T cells and Langerhans cells. The sharply reduced numbers of T cells and Langerhans cells, and the virtual absence of MHC class I expression all suggest that the anagen proximal hair follicle constitutes an area of immune privilege within the hair follicle immune system. Its collapse may be crucial to the pathogenesis of alopecia areata. 14
Inflammatory diseases of the pilosebaceous apparatus are a common problem in dermatological practice, although it is unusual for biopsies to be taken in many of the entities included in this category. It often assists in arriving at a specific diagnosis if the various inflammatory diseases are subdivided into six categories, although it should be recognized at the outset that this subdivision is somewhat arbitrary. These categories are as follows:
• acneiform lesions
• superficial folliculitides
• deep infectious folliculitides
• deep scarring folliculitides
• follicular occlusion triad
• miscellaneous folliculitides.
Acneiform lesions combine inflammation of the pilosebaceous apparatus with the presence of comedones and often scarring as well. Comedones are dilated and plugged hair follicles which may have a small infundibular orifice (closed comedo) or a wide patulous opening (open comedo). Comedones are not confined to acne, being found in senile skin and certain other circumstances (see below).
The other categories in this section are all folliculitides. The term folliculitis refers to the presence of inflammatory cells within the wall and lumen of a hair follicle, while perifolliculitis denotes their presence in the perifollicular connective tissue, sometimes extending into the adjacent reticular dermis. Folliculitis and perifolliculitis are often found together because an inflammatory process in the follicle spills over into the adjacent connective tissue. If the inflammatory process is severe enough, destruction of the hair follicle will ensue. Scarring may also result if the inflammatory process is severe and/or persistent. Five major categories of folliculitis, other than acneiform lesions, can be defined although, as already mentioned, this subdivision is somewhat arbitrary. They will be considered after the acneiform lesions have been discussed.
Acneiform lesions are characterized by the presence of comedones, as well as inflammation of the hair follicle. The inflammatory process frequently extends into the adjacent dermis with the formation of pustules, draining sinuses, and subsequent scarring. The most important entity in this group is acne vulgaris.
Acne vulgaris, an inflammatory disease of sebaceous follicles, is a common disorder that affects a large proportion of the teenage population.15.16.17.18. and 19. Acne vulgaris also affects people with skin of color.20. and 21. The incidence in a recent survey of Asian teenagers in Singapore was 88%. 22 The incidence is low in non-westernized populations. 23 It is usually a mild affliction which improves spontaneously after adolescence. 24 In a small proportion, it produces considerable disfigurement. Severity can impact on the quality of life of the affected individual.25.26.27.28. and 29. Acne can also be found in some neonates, infants, and adults.30.31.32.33. and 34. Infantile acne may be the initial sign of an adrenocortical tumor. 35 Infantile acne has a male predominance. 36 It may result in considerable scarring. 37 Late-onset acne appears to be a special group in which endogenous factors play a major role. 38 A high proportion of female acne is of late onset.39. and 40.
In a study published in 2006, but based on 2004 data, which was a joint project of the American Academy of Dermatology Association and the Society for Investigative Dermatology, acne was the second most costly skin disease after skin ulcers and wounds, accounting for $2.5 billion annually in direct medical costs. 41 Of this amount, $1.74 billion was expended on prescription drugs, and this figure does not include specialty pharmaceuticals, which are often used in the treatment of acne. Incidentally, the prevalence was estimated to be 50.2 million persons. 41
Acne is a polymorphic disorder with such diverse lesions as comedones, papules, pustules, cysts, sinuses, and scars. 15 Scarring can be minimized by early effective treatment.42. and 43. An attempt has been made to classify the scars into several subtypes. 44 The comedones may take the form of tiny white papules known as ‘whiteheads’ (closed comedones) or small papules with a central core, the surface of which is black. These lesions are known as ‘blackheads’ (open comedones). Comedones are not confined to acne, being found in senile skin, 45 in a rare congenital form, 46 in nevus comedonicus, and following exposure to certain chemicals such as coal tar. 47 Only a few inflammatory lesions are present at any one time in mild acne, although comedones may be present and dormant for years. 48 A recent study has confirmed the comedomal origin of the majority of inflammatory acne lesions. 49 However, quite a few cases (28%) appear to arise from normal skin, although some microcomedones may be difficult to visualize. 49
Acne affects the face and, less frequently, the upper part of the trunk. These are sites of maximum density of sebaceous follicles. 16 In one report, acne presented in a zosteriform distribution (‘acne nevus’). 50 In another, the acneiform rash was localized to the site of previous herpes zoster infection. 51 Acne is uncommon in the scalp, suggesting that terminal follicles may have a protective function. 52
Acne vulgaris is of multifactorial origin with both intrinsic and extrinsic factors contributing to the final outcome.53.54.55.56. and 57. There are four principal pathogenetic events: abnormal follicular keratinization with retention of keratinous material in the follicle, increased sebum production, the presence of the Gram-positive anaerobic diphtheroid Propionibacterium acnes, and inflammation.16.58. and 59. These various factors are, in part, interrelated.
The initial event is abnormal keratinization of the infrainfundibular portion of sebaceous follicles, leading to the impaction of adherent horny lamellae within the follicle.60. and 61. The cause of this retention hyperkeratosis is unknown although both the formation of free fatty acids and the follicular deficiency of the fatty acid linoleic acid62 have been implicated at different times. Impacted follicles, which are the precursors of comedones and inflammatory lesions, are not detectable clinically. 60 They are termed ‘microcomedones’. 63 With the recent complete mapping of the P. acnes genome, there is now a better understanding of the causes of the microcomedone. P. acnes biofilm produces a biological glue that holds corneocytes together to form the keratin plug, which leads to the infundibular obstruction. 64 Biofilms are an important defense mechanism of bacteria. Microorganisms within biofilms are 50 to 500 times more resistant to antimicrobial therapies than free-floating (planktonic) bacteria. 64 Isotretinoin and benzoyl peroxide may alter the vitality of the P. acnes biofilm. 65 The microcomedone may not be the central cause of acne, but merely a reflection of the action of P. acnes secreting substances into the sebum as they try to set up their biofilm. 64
The role of sebum is poorly understood. 66 Acne patients have increased sebum secretion by the sebaceous follicles. 62 Sebum production is known to be under the influence of androgens,67. and 68. which are increased in some patients, particularly females, with acne.69.70.71.72.73. and 74. Dehydroepiandrosterone sulfate, the major adrenal androgen, is significantly higher in girls and adult women with acne than in age-matched controls.30.75. and 76. Insulin-like growth factor 1 is also increased in adult women with acne. 76 Androgens also play a role in prepubertal acne in males.77. and 78. There are elevated levels of 17-hydroxyprogesterone in male patients with acne. 79 Of interest is the finding that some women with acne have polycystic ovaries.80. and 81. Premenstrual acne flares may occur.82.83. and 84. Furthermore, the injection of sebum into the skin produces inflammatory lesions that mimic those of acne. 85 The onset of sebum secretion and expansion of the propionibacterial skin flora occur earlier in children who develop acne than in children who do not. 86 Despite these findings a recent report found no correlation between levels of sebum secretion and the number of acne lesions. 87
P. acnes is the bacterial species most consistently isolated from lesions of acne, 88 although it is present in only 70% of early inflammatory lesions. 89 Bacteria are not essential for the formation of comedones. 90P. acnes produces several factors, other than its biofilm, which may be of pathogenetic importance.91.92.93. and 94. These include lipases and proteases, chemotactic factors, and heat shock proteins. 95P. acnes can, in some way, activate the complement system and it may stimulate the release of hydrolases from neutrophils. 92 These may in turn damage the follicular wall, leading to the liberation of the contents of the follicle into the dermis and the consequent inflammatory reaction. P. acnes also has T-cell mitogenic activity. 96 It also triggers cytokine responses in acne by activation of toll-like receptor 2 (TLR2). 97 Toll-like receptors may also result in the accumulation of pus in the acne pustule. 64 The resolution of acne lesions may involve the regulation of CD4+ T-cell responses to P. acnes. 95 Other studies suggest that an overly vigorous immune response to P. acnes may be the fundamental problem in patients with inflammatory acne.98. and 99. The microflora of adolescent, persistent, and late-onset acne is the same. 100 Antibiotic-resistant strains of P. acnes are present in some cases of recalcitrant acne vulgaris.101.102.103. and 104. Phototherapy has been used to treat some of these antibiotic-resistant cases. 105
Many external factors may influence the course of acne vulgaris. 106 These include drugs (halides, isoniazid, various hormones, barbiturates, lithium, etretinate, topical tacrolimus, 107 infliximab,108. and 109. imatinib, 110 epidermal growth factor receptor inhibitors,111. and 112. such as erlotinib,113. and 114. cetuximab, 115 and gefitinib, 116 anabolic steroids, 117 sirolimus, 118 amineptine,119. and 120. the recreational drug ecstasy, 121 and phenytoin (diphenylhydantoin)), cosmetics, soaps and shampoos, tight-fitting masks, 122 industrial chemicals, oils and tar, 123 smoking,124.125. and 126. ultraviolet light, radiation therapy, 127 infections such as infectious mononucleosis, 128 and friction or trauma.129. and 130. The rash associated with the epidermal growth factor receptor inhibitors is sometimes folliculitis131. and 132. or rosacea-like in its appearance.133. and 134. The complications of these inhibitors have been characterized by the eponym PRIDE (papulopustules and/or paronychia, regulatory abnormalities of hair growth, itching, and dryness due to epidermal growth factor receptor inhibitors). It has also developed as an immune reconstitution syndrome in a patient with AIDS after initiation of antiretroviral (HAART) therapy. 135
It has been suggested that diets with a low glycemic index are less likely to result in acne, 23 but this has been questioned.136. and 137. No mention is made these days of the adverse effects of various foods in provoking acne, although occasional patients insist that a certain food exacerbates their disease.136. and 138. A recent study of milk consumption and acne in teenage boys found a positive association between intake of skim milk and acne. 139 An associated commentary urged caution in accepting the results. 140
Acneiform lesions are seen in Apert’s syndrome (acrocephalosyndactyly – OMIM 101200).141. and 142. Its manifestations include craniosynostosis, severe syndactyly of the hands and feet, and dysmorphic facial features. The prevalence in the United States has been estimated to be 15.5 cases per million live births. 143 It is due to a mutation in the fibroblast growth factor receptor 2 (FGFR2) gene at 10q26. 144 Somatic mutations in FGFR2 can produce segmental acne (acneiform nevus). 145 Oral isotretinoin has been used to treat the acne associated with Apert’s syndrome. 146
Acneiform lesions are also seen in pyoderma faciale, although in this condition there are cysts and draining sinuses but no comedones. 147 An acneiform eruption may complicate the use of topical and systemic corticosteroid therapy (steroid acne).148. and 149. There is some suggestion that steroid acne is exacerbated or precipitated in some way by the presence of Malassezia sp. 150 Another form of acne is aquagenic acne, which occurs in some swimmers. It is probably of multifactorial origin, chlorine being only one of many contributing factors. 151
Numerous articles have been written on this subject as evidenced by a methodological review in 2002 which found 140 treatments tested in 251 comparisons, and reported in 250 articles. 154 Since that time Guidelines from the American Academy of Dermatology have been published. 155 They will form the basis of this report.
Topical therapy
Retinoids, 156 benzoyl peroxide, and antibiotics all have level 1 evidence in support of their use. A combination of two of these therapies may be more effective than either alone. This is so with a combination of topical retinoids and topical erythromycin or clindamycin, 157 and the combination of either of these two antibiotics with benzoyl peroxide. 155 There is no evidence relating to the relative efficacy of different retinoids. Salicylic acid can be used when retinoids are not tolerated. Clindamycin and salicylic acid combined are also effective. 158 The use of topical antibiotics can be associated with the development of bacterial resistance. Topical retinoids are both comedolytic and anti-inflammatory while benzoyl peroxide is antimicrobial, weakly comedolytic, but, most importantly, breaks the biofilm around P. acnes. 57
Systemic therapy
The Academy Guidelines suggest that doxycycline and minocycline are more effective than tetracycline. However, a systematic review in 2008 of seven randomized trials concluded that there was insufficient evidence to support the use of one tetracycline over another and that the dose used has no effect on efficacy. 159 Tetracycline was found to be effective in a small study in blocking the acneiform eruption of cetuximab. 115 It should be noted also that the use of minocycline is associated with an increased incidence of autoimmune diseases; the appearance of p-ANCA is a marker for the early development of these diseases. 160 Erythromycin can be substituted in pregnant women and in children. Trimethroprim-sulfamethoxazole, and oral cephalexine have also been used.155. and 161. Isotretinoin is approved for severe, recalcitrant nodular acne and for less severe forms that are resistant to treatment. It is a powerful teratogen. Mood disturbances have also been reported. There is a relatively high rate of relapse (41% in one study) on cessation of the drug. 162 Topical retinoid monotherapy is as effective as the combination of retinoid with minocycline for maintenance therapy. 163 Estrogen-containing oral contraceptives can be useful in the treatment of some women. 155 They are sebosuppressive in their activity. 57 The oral antiandrogens spironolactone and cyproterone (but not finasteride) can be useful in some women.
Photodynamic therapy has also been used to treat patients with inflammatory acne.164. and 165. Pain may occur during active treatment, 166 but subsequent correspondence suggested that other methods of delivering this therapy may be more effective. 167 There is limited evidence for the use of chemical peels, comedone removal, herbal agents, and hypnosis/biofeedback. 155 Lasers and/or surgery may be needed to correct severe acne scarring. Acne scars can be physically and emotionally troublesome to some individuals. 168
The three major components of acne vulgaris are comedones, inflammatory lesions, and scars. A comedo is an impaction of horny cells in the lumen of a sebaceous follicle.15. and 170. Preceding this is the microcomedo, a clinically invisible lesion in which there is only minimal distension of the infrainfundibular canal of a sebaceous follicle, accompanied by increased retention of horny cells and a prominent underlying granular layer.59.60. and 171. There are two types of comedo: a closed comedo (‘whitehead’) with only a small orifice, and an open comedo (‘blackhead’) which in contrast has a wide patulous orifice. 169 Both consist of a cyst-like cavity filled with a compact mass of keratinous material and numerous bacteria. 169 In the closed comedo there are one or two hairs trapped in the lumen and atrophic sebaceous acini, while in the open comedo there are up to 10–15 hairs in the lumen and the sebaceous acini are atrophic or absent.15. and 169. The epithelial lining of comedones is usually thin.
The source of the pigmentation in open comedones (‘blackheads’) is disputed. It has been attributed to the presence of active melanocytes in the uppermost follicle, but a more recent study failed to confirm this. 172 It is now suggested that densely packed, often concentric, horny material, interspersed with sebaceous material and bacterial breakdown products, may be responsible for the observed pigmentation. 172
If comedones rupture, re-epithelialization may eventually occur, producing secondary comedones which may be distorted in shape as a consequence of the residual inflammation and dermal scarring.15. and 169. Epidermal cysts may also form, particularly on the neck. They differ from comedones by their often larger size and the complete absence of sebaceous acini and a pilary unit. 169 Comedones of all types may be dormant for a long period. At any time they may become inflamed. Pseudoacne is the term given to inflammatory papules of the nasal cleft which on histology have keratin granulomas, probably the result of rupture of milia. 173
Inflammatory lesions have traditionally been attributed to the accumulation of neutrophils within microcomedones or comedones with subsequent rupture of the follicle and the formation of a pustule in the dermis. It now appears that there is an even earlier stage which involves the transmigration of lymphocytes into the wall of the follicle associated with increasing spongiosis of the follicular epithelium (Fig. 15.1). 171 This change has been likened to an allergic contact sensitivity reaction. 171 This is followed after 24–72 hours by the accumulation of neutrophils within the follicle, leading to its distension and subsequent rupture. 171 There may be a localized loss of the granular layer in the region of the eventual rupture, suggesting a defect in keratinization in this region. A perifollicular pustule develops following the rupture of the comedo (Fig. 15.2). Lymphocytes, plasma cells, and foreign body giant cells subsequently appear. The follicular epithelium tends to encapsulate the inflammatory mass; sometimes this is followed by the formation of draining sinuses lined by remnants of the follicular epithelium. When the inflammatory process subsides, distorted secondary comedones may result.
Acne vulgaris (early lesion). There is transmigration of lymphocytes through the spongiotic epithelium lining a microcomedone. A few neutrophils are present along the inner edge. (H & E)
Acne vulgaris. A perifollicular pustule is present in the dermis. It contains liberated hair shafts. (H & E)
Scars in acne vulgaris may take the form of localized dermal fibrosis or of hypertrophic scars, even with keloidal changes. Small atrophic pits are quite common. 169 A thin fibrotic dermis, devoid of appendages, is found directly beneath the epidermis-lined pit. Perifollicular fibrosis and elastolysis, 174 dystrophic calcification, osteoma cutis, 175 and localized hemosiderosis176 are other complications of inflammatory acne lesions.
Comedones contain keratinized cells, sebum, organisms, and hairs. 177 Treatment with isotretinoin leads to a reduction in the quantity of this material and a loss of cohesion between the keratinized cells. 178 In early acne, the cells of the infrainfundibulum contain numerous tonofilaments and desmosomes, but fewer lamellar granules than usual. 59
Acne fulminans is a rare, acute form of acne, found usually in young adult males.179. and 180. There is a sudden onset of painful, ulcerated, and crusted lesions accompanied by fever, musculoskeletal pain, and leukocytosis.179. and 181. Lytic lesions of bone develop in 25% of cases.179.182.183. and 184. A subgroup without systemic features has been reported. 185 Acne fulminans has been reported in association with Crohn’s disease, 186 erythema nodosum,187. and 188. and the use of testosterone. 189 It has also been precipitated by the use of isotretinoin in the treatment of acne vulgaris. 190 Familial cases have been reported. 191
The etiology of this condition is unknown, although there is speculation that immune mechanisms are involved. 182 This is supported by the response that occurs to systemic corticosteroid therapy.181. and 192.
Acne fulminans, or another pustular dermatosis such as acne conglobata, palmoplantar pustulosis, hidradenitis suppurativa or pustular psoriasis, may occur as the cutaneous manifestation of SAPHO syndrome (synovitis, acne, pustulosis, hyperostosis, and osteitis).193.194. and 195.
Systemic corticosteroids are the mainstay of therapy for acne fulminans. The use of adjuvant oral retinoids is controversial, as their use for acne vulgaris may precipitate the condition. 190 Cyclosporine (ciclosporin), methotrexate, and infliximab have all been used as single adjuvants with corticosteroids. 194
Comedones are uncommon in acne fulminans. There are extensive inflammatory lesions in the dermis associated with necrosis of follicles and the overlying epidermis. Follicles distended with neutrophils are also present. Severe dermal scarring usually follows the subsidence of the inflammation.
Chloracne is an acneiform eruption caused by systemic poisoning by halogenated aromatic compounds.197.198. and 199. Although the brominated compounds tend to be more toxic, the term ‘chloracne’ stems from the chlorinated version. 200 Industrial exposure is the usual source of the chloracnegens, although exposure to defoliants containing dioxin was encountered in the Vietnam War.201.202.203. and 204. Cutaneous lesions may persist for long periods after the last exposure to the offending chemical.
Chloracne is distinct from other forms of acne. 197 It most often involves the malar crescent, the retroauricular region, and the scrotum and penis. Erythema and pigmentation of the face may also occur. 197 The primary lesion is the comedo, which is intermingled with small cysts. 197 Inflammatory lesions are sparse. Dioxins have also produced areas resembling granuloma annulare and atrophoderma vermiculatum. 197
There is follicular hyperkeratosis with infundibular dilatation forming bottle-shaped and columnar funnels containing keratinous debris. Comedones and keratinous cysts with an attachment to the epidermis also form. 201 Small infundibular cysts appear to be more common than comedones. 199 Small inflammatory foci may be present. Abundant melanin granules impregnate the corneocytes of the infundibular plugs. 199
In the superficial folliculitides, the inflammatory infiltrate is found beneath the stratum corneum overlying a hair follicle and/or in the follicular infundibulum. Disruption of the follicle wall may lead to inflammation of the upper dermis adjacent to the affected hair follicle.
Acute superficial folliculitis, also known as impetigo of Bockhart, is characterized by small pustules developing around follicular ostia and frequently pierced by a hair.205. and 206.Staphylococcus aureus has been implicated in the etiology.
There is a subcorneal pustule overlying the follicular infundibulum. In addition to neutrophils, there are also lymphocytes and macrophages in the infiltrate, which usually extends into the upper follicle and the surrounding dermis. A morphologically similar entity confined to the scalp and possibly related to infection with Propionibacterium acnes has been reported as chronic non-scarring folliculitis of the scalp. 207
There have been several reports of a pustular folliculitis of the face and upper part of the trunk following exposure to sunlight.208.209.210.211. and 212. The lesions usually appear 4–6 hours after the exposure. 213 The mechanism by which exposure to ultraviolet light results in folliculitic lesions remains to be elucidated, although the condition may be related to acne vulgaris and acne estivalis. 210
Acne necrotica (acne varioliformis) is a rare dermatosis of adults, consisting of crops of erythematous, follicle-based papules that become superficially necrotic, umbilicated, and crusted, with subsequent healing which produces a depressed varioliform scar.214.215. and 216. Only a small number of active lesions may be present at any time. They develop on the frontal hairline, forehead, and face and sometimes on the upper part of the trunk.
Acne necrotica miliaris has been regarded as a pruritic, non-scarring variant of acne necrotica in which follicular vesiculopustules develop on the scalp. 214 This condition has been regarded as nothing more than neurotic excoriations superimposed on a bacterial folliculitis, an etiology that has also been proposed for acne necrotica itself. 217
Early lesions show an intense perivascular and perifollicular lymphocytic infiltrate extending to the mid dermis and associated with prominent subepidermal edema. The infiltrate also extends into the wall of the upper part of the follicle and into the epidermis, where there is associated spongiosis and death of individual keratinocytes. Later, there is confluent necrosis of the upper follicle, the epidermis and dermis. At this stage neutrophils are seen in the upper follicle and the adjacent dermis. A florid superficial folliculitis and perifolliculitis are sometimes present (Fig. 15.3).
Acne necrotica. Confluent necrosis involves the upper follicle and adjacent epidermis and papillary dermis. An adjacent follicle shows a superficial folliculitis. (H & E)
Biopsies of acne necrotica miliaris may show superficially inflamed excoriations, centered on hair follicles. 217 It is unusual to have an intact lesion biopsied; presumably a superficial folliculitis would be seen.
A necrotizing folliculitis is a rare cutaneous manifestation of the acquired immunodeficiency syndrome (AIDS) or its prodromes. 218
Although the folliculitis and perifolliculitis may not be confined to the superficial follicle, this condition is classified with the superficial folliculitides because the accompanying necrosis is confined to the upper part of the follicle and the adjacent epidermis and superficial dermis, characteristically in a wedge-shaped area. 218 There is fibrinoid necrosis of vessels at the apex of the wedge.
A spectrum of other folliculitides is also seen in HIV-infected patients including acute folliculitis due to bacteria and/or yeasts, lymphocytic perifolliculitis, eosinophilic folliculitis, perifolliculitis with mixed inflammation, and follicular rupture with granulomatous perifolliculitis. 219
Eosinophilic (pustular) folliculitis is a heterogeneous group of disorders with several clinical subsets:
• the classic form, eosinophilic pustular folliculitis (Ofuji’s disease)
• HIV-associated eosinophilic pustular folliculitis
• pediatric eosinophilic pustular folliculitis
• fungal and parasitic eosinophilic folliculitis
• a miscellaneous group.
The classic form, eosinophilic pustular folliculitis (Ofuji’s disease), is a rare, chronic dermatosis, first described in the Japanese220.221. and 222. but now reported occasionally in white and other races.223.224.225.226.227. and 228. There are recurrent, sterile, follicular papules and pustules with a tendency to form circinate plaques.229.230. and 231. These may show central clearing with residual hyperpigmentation. ‘Seborrheic areas’, such as the face, trunk, and extensor surface of the proximal part of the limbs, 232 are usually involved but in 20% of cases the non-hair-bearing palms and soles may also be involved. 229 For this reason, the designations ‘eosinophilic pustular dermatosis’233 and ‘sterile eosinophilic pustulosis’ have been suggested as more appropriate titles. There is a male preponderance. 228 The mean age at presentation in one series was 35 years. 234 A peripheral leukocytosis and eosinophilia are often present. A case that was exacerbated by pregnancies has been reported. 235 Another case was associated with pathergy. 236
The condition reported in two brothers as ‘circinate eosinophilic dermatosis’ has some similarities. 237
The etiology of eosinophilic pustular folliculitis is unknown. Interestingly, a similar lesion has been reported in dogs. 238 Various immunological abnormalities have been reported in some patients, but this is not a constant feature.239. and 240. Circulating antibodies to basal cell cytoplasm, 241 and intercellular antigens have been noted. 242 Chemotactic factors have also been isolated from the skin. 243 More recently it has been suggested that the production of nitric oxide by eosinophils may have a pathogenetic role. 244
HIV-associated (immunosuppression-associated) eosinophilic pustular folliculitis has been regarded as a subset of the pruritic papular eruption of human immunodeficiency virus infection.231.245.246.247.248.249.250.251.252. and 253. It differs from the classic form (Ofuji’s disease) by the severe pruritus, the absence of circinate and palmoplantar lesions, and the less frequent involvement of the face. 254 Coexisting follicular mucinosis has been reported in some patients.255. and 256. It has been suggested that HIV-associated eosinophilic folliculitis is an autoimmune disease with the sebocyte or some constituent of sebum acting as the autoantigen. 257 Immunohistochemistry shows increased expression of interleukin-4, and -5, as well as eotaxin. 258 In one patient, the eruption appeared to be related to the use of foscarnet therapy. 259 Although the onset of eosinophilic folliculitis may be initiated by antiretroviral therapy, eosinophilic folliculitis may respond favorably to treatment with this therapy. 260
Pediatric (childhood) eosinophilic pustular folliculitis is usually confined to the scalp, although grouped aggregates of follicular pustules can occur on the face, extremities, and trunk in some patients.261.262.263. and 264. Onset can be as early as the first day of life. 265 It is seen most frequently in white people but Japanese cases occur. 266 It usually has a self-limited course. This condition is no longer regarded as a variant of eosinophilic folliculitis as interfollicular inflammation is sometimes the predominant feature. Eosinophilic pustulosis appears to be an appropriate designation for these cases. Ziemer and Böer have questioned the existence of this variant, stating that previously reported cases encompass a spectrum of eosinophil-rich dermatoses including scabies and other bite reactions. 267
Fungal eosinophilic folliculitis is usually a localized disease, characterized by erosive and pustular plaques.268. and 269.Trichophyton rubrum can produce a folliculitis that is histologically identical to eosinophilic pustular folliculitis. 270 Larva migrans, Toxocara canis, and scabies may be associated with an eosinophilic folliculitis.271. and 272.
The miscellaneous group includes patients in whom bacteria, such as Pseudomonas, have been isolated and patients with myeloproliferative or other hematological disorders.273.274.275. and 276. It has been reported in association with pulmonary eosinophilia, 277 and following allogeneic peripheral blood stem cell transplantation. 278 Nine HIV-negative patients with an atopic diathesis have been reported with ulcerative and/or nodular plaques mainly on the face and/or extremities, sometimes in an annular configuration. Other necrotizing variants have been reported.279. and 280. The histology was that of a necrotizing eosinophilic folliculitis. These cases appear to be the ‘eosinophilic equivalent’ of sterile neutrophilic folliculitis with perifollicular vasculopathy (see p. 410). Drugs such as allopurinol, carbamazepine, and minocycline have been associated with an eosinophilic folliculitis.281.282. and 283. It has also followed the use of a fentanyl-TTS patch, 284 and chemotherapy. 285 Rarely, pemphigus vegetans may present as an eosinophilic folliculitis. 286 A case associated with the nevoid basal cell carcinoma syndrome resolved after removal of the jaw cyst associated with the syndrome. 287
The treatment of choice for the classic type of eosinophilic pustular folliculitis is indomethacin but relapse is common unless maintenance or adjuvant therapy is used.234.279. and 288. Tacrolimus, and much less often pimecrolimus, have been used for treatment failures.289.290. and 291. Dapsone, 292 isotretinoin, naproxen, 293 metronidazole, 294 doxycycline, 295 sequential interferon-γ, and cyclosporine, 296 have all been used for one or more patients. Patients with HIV-associated disease have been treated with indomethacin, narrow-band UVB phototherapy, 297 and tacrolimus. 298
The various clinical subsets of eosinophilic folliculitis have a similar histological appearance. 263 There is eosinophilic spongiosis and pustulosis involving particularly the infundibular region of the hair follicle. The infiltrate often extends into the attached sebaceous duct and sebaceous gland. Most follicles are preserved, but some show disruption or destruction of the wall by the inflammatory infiltrate. 223 Follicular necrosis and folliculocentric necrotizing eosinophilic vasculitis were features of the cases reported in association with an atopic diathesis (see above). 299 In addition to the eosinophils, there are variable numbers of neutrophils and some mononuclear cells; neutrophils are usually sparse. 263 There is also a moderately dense, perivascular and perifollicular inflammatory cell infiltrate composed of lymphocytes, eosinophils, mast cells, and macrophages. 300 A PAS or silver methenamine preparation should always be examined, as dermatophyte infections occasionally give a similar appearance.241. and 301.
Lesions on the palms and soles show subcorneal and intraepidermal pustules. There is a variable inflammatory infiltrate in the underlying dermis.
Infundibulofolliculitis is mentioned here for completeness, although it is discussed in further detail with the spongiotic tissue reaction (see p. 99). The histopathological changes are those of follicular spongiosis. A few neutrophils may be found in the spongiotic infundibulum or in the keratin plug which is sometimes present in the involved follicle. A variable mononuclear cell infiltrate usually surrounds the upper dermal portion of the hair follicle.302. and 303.
In this group of folliculitides the inflammatory process involves the deep portion of the hair follicle, although both superficial and deep inflammation may be present (Fig. 15.4). The etiological agents include bacteria, fungi, and viruses and are not always easily identified in routine tissue sections. A folliculitis is an uncommon presentation of secondary syphilis, and of a nematode infestation. 304
Acute folliculitis of fungal etiology involving both the superficial and deep portion of the follicle. (H & E)
A furuncle (boil) is a deep-seated infection centered on the pilosebaceous unit. 305 Boils commonly occur at sites of friction by clothing such as the back of the neck, the buttocks and inner aspect of the thighs. The lesion begins as a painful, follicular papule with surrounding erythema and induration. 305 The center usually becomes yellow, softens and discharges pus. A rim of desquamation often surrounds the infected hair follicle. 306 Healing takes place with minimal scarring. A carbuncle is a coalescence of multiple furuncles which may lead to multiple points of drainage on the skin surface. There are often constitutional symptoms.
Staphylococcus aureus is the organism most often involved. 307
A furuncle consists of a deep dermal abscess centered on a hair follicle. This is usually destroyed, although a residual hair shaft is sometimes present in the center of the abscess. There is often extension of the inflammatory process into the subcutis. The overlying epidermis is eventually destroyed and the surface is covered by an inflammatory crust.
Pseudomonas folliculitis is usually caused by Pseudomonas aeruginosa. It presents as an erythematous follicular eruption which may be maculopapular, vesicular, pustular, or polymorphous.309. and 310. It usually involves the trunk, axillae, and proximal parts of the extremities. There may be constitutional symptoms. 311 Lesions develop 8–48 hours after recreational exposure to the organism, which is found in contaminated sponges, whirlpools, and hot tubs.312.313.314. and 315. Organisms other than Pseudomonas may be responsible for hot tub (spa bath) folliculitis. 316 Spontaneous clearing usually occurs within a week. Sporadic cases, without recreational exposure, also occur. 317
There is an acute suppurative folliculitis which may be both superficial and deep (Fig. 15.5). If disruption of the follicular wall occurs, dermal suppuration may result. Attempts to demonstrate organisms in conventional histological preparations are usually unsuccessful.
‘Hot tub’ folliculitis. (A) A superficial and deep folliculitis is present. (B) Rupture has occurred into the dermis. (H & E)
A folliculitis caused by Gram-negative bacteria may occur as a complication of prolonged antibiotic therapy in patients with acne vulgaris. 318 Most of these infections are caused by a subgroup of lactose-fermenting bacteria, resulting in superficial pustules grouped around the nose. Pseudomonas aeruginosa has also been implicated in this clinical setting. 319 In others, deep nodular and cystic lesions occur as a result of infection by species of Proteus. 318Citrobacter diversus, Acinetobacter baumanii, 320Klebsiella sp., 321Escherichia coli, and Enterobacter sp. have also been implicated.322. and 323. In immunocompromised patients, organisms which are not usually pathogens, such as Micrococcus, have been involved. 324
Bacteria, possibly complicating the application of various oils to the skin, have been implicated in a pustular eruption of the legs seen in parts of Africa and India and known as dermatitis cruris pustulosa et atrophicans. 325
Salmonella dublin was isolated from one case of widespread folliculitis. 326
Both a superficial and deep folliculitis may be present in these bacterial folliculitides. There is variable involvement of the perifollicular dermis.
The pilosebaceous follicle may be infected with herpes simplex virus type I. Vesicular or pustular lesions may not be obvious clinically. 327 Recently it has been shown that infections with varicella zoster virus (VZV) are more common as a cause of a folliculitis than herpes simplex virus. 328 A granulomatous folliculitis has been reported as a manifestation of post-herpetic isotopic response.329. and 330.
In herpes folliculitis there is often partial or complete necrosis of the follicle with exocytosis of lymphocytes into the follicular wall and the attached sebaceous gland. 328 Sometimes there is adjacent dermal necrosis. The epidermis sometimes shows the typical features of herpetic infection. Epidermal changes are said to be uncommon in herpes zoster-related folliculitis. 328 At other times, a ‘bottom heavy’ perivascular and interstitial dermal inflammatory cell infiltrate, which may simulate a pseudolymphoma or lymphoma, is the only clue. 331 This finding necessitates the cutting of multiple deeper sections in search of an involved hair follicle. The most consistent finding in herpes folliculitis is lymphocytic folliculitis and perifolliculitis. 328 Inclusion bodies and multinucleate cells are not always found in the follicular epithelium. A syringitis may accompany the folliculitis. 332
Viral-associated trichodysplasia (pilomatrix dysplasia, cyclosporine-induced folliculodystrophy, 333 virus-associated trichodysplasia spinulosa334. and 335.) is a recently described follicular dystrophy of presumptive viral origin associated with immunosuppression.336.337. and 338. The patients present with numerous, disfiguring, papular, and spiny lesions, predominantly affecting the central face. 339 Alopecia may be present elsewhere on the body. 340 Ultrastructurally, there are intranuclear viral particles consistent with polyoma virus. 334 There are anecdotal reports that topical cidofovir, an antiviral agent, has resulted in improvement in the condition. 339
In viral-associated trichodysplasia (Fig. 15.6) there is dilatation and keratotic plugging of the infundibula with marked dystrophy and expansion of the inner root sheath with enlarged, irregular, trichohyaline granules and numerous apoptotic cells. There is bulbar distension and lack of hair shaft formation.334. and 339. Inflammation is usually mild. 341
Viral-associated trichodysplasia. The patient was on immunosuppressive therapy. (H & E)
Fungal elements may be seen on or within the hair shafts in certain dermatophyte infections, particularly tinea capitis. Various organisms may be involved, particularly Trichophyton tonsurans, Microsporum canis, and M. audouinii. 342 Sometimes an inflamed boggy mass, known as a kerion, develops.
There is variable inflammation of the follicle and perifollicular dermis. If disruption of the hair follicle occurs, a few foreign body giant cells may be present. Hyphae and arthrospores may be found within the hair shaft or on the surface, depending on the nature of the infection. PAS or methenamine silver preparations are usually required in order to demonstrate the fungal elements.
Abscess formation with partial or complete destruction of hair follicles occurs in a kerion.
Pityrosporum folliculitis, resulting from infection of the follicle by Malassezia sp. (Pityrosporum), has been described on page 593. The small oval yeast responsible can be seen within the inflamed follicle and may be found in the adjacent dermis following rupture of the follicle.
In the deep scarring group there is severe folliculitis involving the deep part of the follicle and often the upper part as well. Rupture of the follicle and its contents into the dermis leads to eventual scarring of variable severity. It is usually mild in folliculitis decalvans, but quite marked in folliculitis keloidalis nuchae. A similar picture can be seen following severe petrol burns of the skin.
Folliculitis decalvans is a chronic form of deep folliculitis that usually occurs on the scalp as oval patches of scarring alopecia at the expanding margins of which are follicular pustules.205. and 343. Any or all of the hairy areas of the body may be involved. Folliculitis barbae (lupoid sycosis) is a related condition confined to the beard area, while epilating folliculitis of the glabrous skin is the name used in the earlier literature for a related condition involving the legs. 344 Folliculitis decalvans has been reported in identical twins. 345
Folliculitis decalvans usually runs a prolonged course of variable severity. The development of squamous cell carcinoma is a rare complication. 346 The etiology is unknown, although Staphylococcus aureus is sometimes cultured from the lesions. 347 It appears that early lesions are characterized by an infiltration of activated T-helper cells. IL-8 and ICAM-1 may contribute to the infiltration of neutrophils. 348
The very existence of this entity has been questioned, although the author still uses this diagnosis. Ackerman states that it is best to eschew the term, 349 while Sperling believes that most cases represent a highly inflammatory form of central centrifugal cicatricial alopecia. 350
Tufted hair folliculitis (see p. 430) has been regarded as a clinicopathological variant of folliculitis decalvans, 351 but as it can be associated with other disease processes, it is best regarded as a distinct process. 352
Initially there is a folliculitis; this is followed by disruption of the follicular wall and liberation of the contents of the follicle into the dermis (Fig. 15.7). The dermis adjacent to the destroyed follicle contains a mixed inflammatory cell infiltrate. Plasma cells are sometimes present in the infiltrate, particularly in resolving lesions. Foreign body giant cells may form around the hair shafts lying free in the dermis. Variable scarring results, but this is never as severe as in folliculitis keloidalis nuchae.
Folliculitis decalvans. The patient had a scarring alopecia. There is early disruption of the wall of an inflamed follicle. (H & E)
Folliculitis keloidalis nuchae, also known as acne keloidalis, is a rare, idiopathic, inflammatory condition of the nape of the neck, restricted almost exclusively to adult males.353.354.355. and 356. About 90% of patients are below the age of 40 years. 357 It is a form of primary scarring alopecia of the occipital and nuchal region. 358 It is more common in blacks of African origin. There are follicular papules and pustules which enlarge, forming confluent, thickened plaques, sometimes with discharging sinuses.353. and 359. The lesions have caused secondary cutis verticis gyrata in affected persons.360. and 361. Scarring results from this chronic inflammatory process. Surgery is sometimes required to manage the condition, when treatment with topical corticosteroids/antibiotics and oral antibiotics fails.362. and 363.
The pathogenesis of this condition and the reasons for its occipital localization are not known. Postulated mechanisms include a seborrheic constitution, incurving hairs resulting from recurrent low-grade trauma (for example, by football helmets),356. and 364. the use of antiepileptic drugs or cyclosporine,365. and 366. and an increase in mast cell numbers in the occipital region.367.368. and 369. Tinea capitis was the cause in one case. 370
There is an initial folliculitis with subsequent rupture and destruction of the follicle and liberation of hair shafts into the dermis (Fig. 15.8). 354 Usually, by the time a biopsy is taken, there is already dense dermal fibrosis with a chronic inflammatory cell infiltrate which includes numerous plasma cells. Hair shafts are present in the dermis and these are surrounded by microabscesses and/or foreign body giant cells. Sinus tracts may lead to the surface. Sometimes there are claw-like epidermal downgrowths associated with the transepidermal elimination of hair shafts and inflammatory debris. 371 Involved follicles may show tufted hair folliculitis while intact follicles at the margins may show polytrichia.353. and 372. Keloid fibers develop within the dense fibrous tissue in some cases. 353
Folliculitis keloidalis. (A) Hair shafts have been extruded into the dermis during the inflammatory destruction of the hair follicles. (B) Fibrosis of the dermis is also present. (H & E)
The follicular occlusion triad refers to hidradenitis suppurativa, dissecting cellulitis of the scalp, and acne conglobata. These three conditions constitute a form of deep scarring folliculitis: they are grouped together on the basis of their presumed common pathogenesis of poral occlusion followed by bacterial infection. 373 The presence of draining sinuses is a further characteristic feature of this group. Rarely, cases occur with exophytic abscesses and fibrosis in unusual sites, such as the chin, that have all the features of the follicular occlusion triad. 374 It has been suggested that pilonidal sinus is a related entity. These follicular occlusion disorders may coexist. 375
Acne inversa (hidradenitis suppurativa) is a chronic, relapsing, inflammatory disorder involving the terminal hairs of one or more apocrine gland-bearing areas, which include the axillae, groins, pubic region, and perineum.376.377.378.379.380.381. and 382. The author has responded to pleas to abandon the term hidradenitis suppurativa because it is a misnomer, in favor of acne inversa, 383 which may be another. 384 The term hidradenitis suppurativa appears to be the preferred one in Europe. 385 The prevalence estimate is 1 : 300. 386 There are recurrent, deep-seated inflammatory nodules, complicated by draining sinuses and subsequent scarring. The disease causes a high degree of morbidity; pain is often a problem.387. and 388. The development of squamous cell carcinoma is a late and rare complication.389.390.391.392. and 393. The tumors arise from the sinus tracts. 394 Other clinical features include the presence of comedones in retroauricular and apocrine sites, 395 a female predominance,396. and 397. and a genetic predisposition.398.399. and 400. Recently one Chinese family with the disease was mapped to chromosome 1p21.1–1q25.3. 401 Interestingly, frequent losses in chromosomal region 1p21–p22 have been associated with diffuse malignant peritoneal mesothelioma, a rare neoplasm reported recently in association with acne inversa. 401 Prepubertal onset is rare. 402 Associations with lithium therapy, 403 Dowling–Degos disease, 404 cigarette smoking,405.406. and 407. obesity, 385 and Crohn’s disease have been reported.408.409. and 410. Host defense mechanisms are usually normal, except in some severe cases, where a reduction in T lymphocytes, and the presence of dysfunctional neutrophils have been documented.411. and 412. Monocytes secrete less TNF-α and IL-6 than do cells from healthy controls, 413 but toll-like receptor 2 is strongly expressed. 414 There is now good evidence that acne inversa is an androgen-dependent disorder,415.416.417.418. and 419. although how this relates to the poral occlusion by keratinous material is uncertain. 420 This occlusion is followed by an active folliculitis with, in some cases, a secondary apocrinitis and apocrine destruction. Apoeccrine glands, which drain directly onto the epidermal surface, appear to be uninvolved. 421 Coagulase-negative staphylococci are the most common isolate; 422 however, the microbiological flora is not constant. 410 It is possible that an abnormal immune response against bacteria, colonizing the follicular infundibulum, may be one of the initial events leading to acne inversa. 423
The treatment of acne inversa (hidradenitis suppurativa) is often ineffective. 424 Initial management is often used in conjunction with other treatment modalities. Initial measures include cessation of smoking, weight loss, and avoidance of irritation in affected areas. 386 Systemic and/or topical antibiotics are usually used. Topical clindamycin results in significant improvement; 425 it may be given orally, in combination with rifampicin. 426 Dapsone and corticosteroids have helped some patients, but relapse occurs on the tapering of any steroids. The anti-androgen finasteride has been effective in some patients. 386 The biologics such as infliximab,407.424. and 427. efalizumab, 428 and etanercept425.429. and 430. have helped some patients but their potential side effects need to be considered. 431 Carbon dioxide laser has also been used. 432
In established lesions, there is a heavy, mixed inflammatory cell infiltrate in the lower half of the dermis, usually with extension into the subcutis. 436 Chronic abscesses are present in active cases and these may connect with sinus tracts leading to the skin surface (Fig. 15.9). The sinuses are usually lined by stratified squamous epithelium in their outer part. They contain inflammatory and other debris. 437 Some of these tracts are probably residual follicular structures.438. and 439.
Acne inversa (hidradenitis suppurativa). (A) There is acute and chronic inflammation in the dermis and an epithelial downgrowth (probably of follicular origin) ‘draining’ the area. There is hemorrhage at the deep edge. (B) Inflammation of the apocrine glands is present in this unusual case. (H & E)
Granulation tissue containing inflammatory cells and occasional foreign body giant cells is present in up to 25% of cases. 409 Epithelioid granulomas were present in one case with coexisting Crohn’s disease. 409Extensive fibrosis with destruction of pilosebaceous follicles and of apocrine and eccrine glands usually ensues. Inflammation of the apocrine glands may be present in the axillary region in about 20% of cases. 435 Perieccrine inflammation is seen in approximately one-third of cases, from all sites. 421
In early lesions, there is folliculitis and perifolliculitis involving the lower part of the follicle. 440 The infundibulum is usually dilated and contains keratinous material and inflammatory debris. 441 These findings support the notion that acne inversa is primarily a follicular disease, but apocrine glands can be primarily involved in a minority of axillary lesions. 435
Dissecting cellulitis of the scalp, also known as perifolliculitis capitis abscedens et suffodiens (Hoffmann’s disease), is an extremely rare disease characterized by the appearance of tender, suppurative nodules with interconnecting draining sinuses and subsequent scarring.442.443. and 444. Patchy alopecia usually overlies the lesions, which have a predilection for the vertex and occipital scalp. There is a predilection for young adult black males. 445 Familial occurrence has been reported. 446 Dissecting cellulitis may occur alone or in association with the other follicular occlusion diseases – hidradenitis suppurativa and acne conglobata. 375 It has also been associated with an arthropathy, which may be axial, 447 and a marginal keratitis. 448 The development of squamous cell carcinoma is a rare complication. 449
The etiology is unknown, but follicular occlusion is presumed to play a role. Bacterial superinfection appears to be a secondary event.450. and 451. Harsh trauma was implicated in one case. 452
Treatment with oral isotretinoin has been successful in several cases.445.453. and 454. Quinolone antibiotics may be used as adjuvant therapy. 451 Electron beam radiation, 455 and an 800 nm pulsed diode laser have also been used. 456 A recent report documents the successful use of infliximab, a monoclonal antibody to TNF-α. 457
The earliest lesion is a folliculitis and perifolliculitis with a heavy infiltrate of neutrophils leading to abscess formation in the dermis. Draining sinuses may develop and in later lesions the infiltrate becomes mixed. Variable destruction of follicles ensues.
Acne conglobata is an uncommon dermatosis, occurring almost exclusively in males and commencing after puberty. There are small and large, tender, inflamed nodules, cysts, and discharging sinuses that eventually heal, leaving disfiguring scars. 459 Lesions may develop in any hair-bearing area, particularly the trunk, buttocks, and proximal parts of the extremities. 460 The lesions frequently become secondarily infected with bacteria. 461 The distribution is much wider than in hidradenitis suppurativa. Acne conglobata has been reported in association with lichen spinulosus in a man seropositive for the human immunodeficiency virus (HIV). 462 There is also an eruption resembling pityriasis rubra pilaris in these HIV-positive patients. 463 It has also followed pregnancy. 464 Malignant degeneration can develop in lesions of acne conglobata of long standing. 459
Isotretinoin, often in conjunction with prednisone, is the preferred treatment for severe acne conglobata. Doxycycline or oral trimethoprim-sulfamethoxazole is used for secondary infections. There is a recent report on the use of infliximab in this disease. Results were good. 461
The appearances are similar to hidradenitis suppurativa, with deep abscesses and mixed inflammation, foreign body granulomas, and discharging sinuses. 437 Comedones are often present.
There are several folliculitides that do not fit appropriately into the categories already discussed. They include pseudofolliculitis, pruritic folliculitis of pregnancy, and perforating folliculitis. Follicular pustules have also been reported in association with toxic erythema, 465 cyclosporine therapy, 466 acute myeloblastic leukemia, 467 inhibitors of epidermal growth factor receptor,131.132. and 468. and in young individuals with acne treated with systemic steroids. 205 A lymphocytic folliculitis was present in a patient with an intensely pruritic eruption on the back, which developed after she stopped dieting. 469 A florid folliculitis (hyperplastic folliculitis) may develop in organ transplant recipients. It may be related to the taking of cyclosporine, by these patients (see below). 470
‘Necrotizing infundibular crystalline folliculitis’ is the term used by Kossard et al for the peculiar folliculitis that developed in a young adult female with a background of acne. 471 There were folliculocentric facial papules corresponding to filamentous plugs in an amorphous matrix bulging into the upper dermis through a degenerate infundibular wall. 471
The treatment of the folliculitis associated with the epidermal growth factor inhibitors has been successful with topical metronidazole and oral tetracyclines. 131
Pseudofolliculitis is a common disorder of adult black males. It is usually confined to the beard area of the face and neck, 472 but rarely the scalp, 473 pubic area, 474 and legs475 may be involved. Pseudofolliculitis barbae (‘razor bumps’) refers to lesions of the beard area. 476 Hypertrophic pseudofolliculitis barbae has been reported in renal transplant recipients receiving cyclosporine. 477 Pseudofolliculitis consists of papules and pustules in close proximity to hair follicles. Scarring and keloid formation sometimes result. 478
Pseudofolliculitis is an inflammatory response to an ingrown hair. Hair shafts in black people have a tendency to form tight coils and, following shaving, the sharp ends may pierce the skin adjacent to the orifice of the follicles. 473 Dermoscopy has been used to confirm the diagnosis. 476
The treatment of pseudofolliculitis is challenging. Behavioral changes with a minimization of overshaving may assist. 177 Benzoyl peroxide, clindamycin, and retinoids have been used. Surgical or laser depilation may be necessary. 476 The neodymium:yttrium aluminum garnet (YAG) laser is a safe and effective option for reducing hair and subsequent papule formation. 479
Surprisingly, little has been written about the histopathology of this common disorder. There are parafollicular inflammatory foci which are initially suppurative. Small foreign body granulomas and a mixed inflammatory cell infiltrate are present in older lesions. Variable scarring may ensue. In some instances, epithelium grows down from the surface to encase both the hair and the inflammatory response, assisting in their eventual transepithelial elimination.
Pruritic folliculitis of pregnancy is a rare dermatosis in which pruritic, erythematous papules develop in a widespread distribution in the latter half of pregnancy. 480 The lesions clear spontaneously at delivery or in the postpartum period. There is no adverse effect on fetal well-being. 481 The etiology is unknown, but on the basis of a case with elevated androgens, it has been suggested that this condition is a ‘form of hormonally induced acne’. 482 This finding has not been confirmed in a subsequent study. 481Malassezia yeasts do not appear to be the cause either.483. and 484.
Perforating folliculitis is manifested by discrete, keratotic, follicular papules with a predilection for the extensor surfaces of the extremities and the buttocks. 486 It may persist for months or years, although periods of remission often occur. Disease associations have included psoriasis, 487 juvenile acanthosis nigricans, HIV infection, 488 primary sclerosing cholangitis,489. and 490. and renal failure, often in association with hemodialysis.486. and 491. It has recently been reported following the use of the inhibitors of tumor necrosis factor-α, infliximab and etanercept. 492
The features of perforating folliculitis associated with renal failure (see p. 324) may overlap those of reactive perforating collagenosis and Kyrle’s disease486 (the latter disease has been regarded by some as a variant of perforating folliculitis). 493 Lesions associated with renal failure are often pruritic, in contrast to the asymptomatic lesions of the majority of cases. 494
The etiology of perforating folliculitis is unknown, although minor mechanical trauma may play a role. It has been suggested that perforation of the epithelium is the primary event and that it is not a primary disorder of transepithelial elimination. 494
There is a dilated follicular infundibulum filled with keratinous and cellular debris. A curled hair shaft is sometimes present. The follicular epithelium is disrupted in one or more areas in the infundibulum. The adjacent dermis shows degenerative changes involving the connective tissue, and sometimes collagen and elastic fibers are seen entering the perforation (Fig. 15.10). The elastic fibers are not increased as in elastosis perforans serpiginosa. A variable inflammatory reaction is present in the dermis in this region and sometimes a granulomatous perifolliculitis develops. Although a few neutrophils may be present in the infiltrate, they are never as plentiful as in pityrosporum folliculitis, which often ruptures into the dermis. Sometimes the follicular localization of perforating folliculitis is not appreciated unless serial sections are examined.
Perforating folliculitis. Degenerate collagen and elastic tissue are entering the perforated follicle. The patient had chronic renal failure. (H & E)
The term ‘follicular toxic pustuloderma’ has been used for an acute pustular eruption with follicular localization. Most cases have been associated with the ingestion of drugs, particularly antibiotics, although in others an enterovirus infection has been incriminated. 497 As the lesions are not always follicle-based, the terms ‘toxic pustuloderma’ and ‘acute generalized exanthematous pustulosis’ are now used (see p. 132).
The term ‘sterile neutrophilic folliculitis with perifollicular vasculopathy’ was coined by Magro and Crowson for a distinctive cutaneous reaction pattern, usually accompanying systemic diseases such as inflammatory bowel disease, Reiter’s disease, Behçet’s disease, hepatitis B, and various connective tissue diseases. 498 It may present clinically as a folliculitis or a vasculitis or with vesiculopustular or acneiform lesions, predominantly on the legs, arms, and upper back. Arthritis, fever, and malaise are often present.
The reported cases showed a neutrophilic or suppurative and granulomatous folliculitis accompanied by a folliculocentric neutrophilic vascular reaction of Sweet’s-like or leukocytoclastic vasculitis subtypes. 498
Pseudolymphomatous folliculitis is a subset of cutaneous lymphoid hyperplasia that is found at all ages and in both sexes. 499 It is almost exclusively a solitary lesion on the face measuring approximately 1 cm in diameter. 500 The lesions often regress after incisional biopsy.
A review of 55 cases of cutaneous lymphoid hyperplasia (‘pseudolymphoma’) from Japan revealed 19 cases that were reclassified as pseudolymphomatous folliculitis. 501
Pseudolymphomatous folliculitis has a dense dermal lymphocytic infiltrate simulating cutaneous lymphoma. The walls of the hair follicles are enlarged and irregularly deformed with their epithelial outline blurred by a lymphocytic infiltrate. Atypical lymphocytes are often present, leading to a misdiagnosis of lymphoma. Of the 15 cases reported in one series, 10 were composed predominantly of B cells and the remainder predominantly of T cells. 499 Increased numbers of dendritic cells expressing S100 and CD1a are present in the perifollicular region. In the series of 19 cases from Japan, pseudolymphomatous folliculitis was identified by the presence of activated pilosebaceous units with abundant CD1a+, S100 protein+ T-cell-activated dendritic cells. 501 The relationship between this entity and Kossard’s folliculotropic T-cell lymphocytosis is unknown as CD1a and S100 were not performed. 502
Hair shafts may be abnormal as a result of an intrinsic defect, either congenital or acquired, in the hair shaft itself or because of the deposition or attachment of extraneous matter such as fungi, bacteria, or lacquer. 503 In either case, structural weakness of the hair shaft may occur; the resulting hair breakage and loss may be severe enough to produce alopecia. Some hair shaft abnormalities may be a component of a systemic disease. 504 Examination of scalp hair samples may aid in the diagnosis of pediatric disorders. 505
Brief mention will be made of hair graying, a variation in the human hair of considerable interest to persons involved. Graying appears to be a consequence of an overall and specific depletion of melanocytes in the hair bulbs and the outer root sheath. 506 Hair pigmentation is regulated by several factors including the interaction of the ligand stem cell factor (SCF) with its class III receptor tyrosine kinase, c-kit. An interruption of SCF/c-kit signal transduction results in hair depigmentation. 507 Treatment with some of the newer tyrosine kinase inhibitors may result in reversible hair depigmentation. 507 Gray hair has developed in children taking triptorelin, a drug used for the treatment of precocious puberty. 508
Several clinical classifications of hair shaft abnormalities have been proposed.503.509.510. and 511. One such classification distinguishes the structural defects with increased fragility from those without this characteristic, as only the cases in the former group (monilethrix, pili torti, trichorrhexis nodosa, trichothiodystrophy, Netherton’s syndrome, and Menkes’ syndrome) present clinically with patchy or diffuse alopecia. 509 Another clinical approach has been to separate off those conditions associated with ‘unruly hair’, namely woolly hair, acquired progressive kinking of hair, pili torti, and rare cases associated with brain growth deficiency. 512 One case that defies orderly classification has been called ‘cutaneous pili migrans’. In that case, a 7 cm long submerged hair extended as a blue line just below the skin surface. 513 There was no associated inflammation. Other examples of this phenomenon, resulting from implantation of exogenous hair shafts, have been reported. One case involved the glans penis, 514 and another the sole of the foot of a child. 515
The classification to be followed here is morphologically based and is similar to the one proposed by Whiting. 503 Four major groups exist:
• fractures of hair shafts
• irregularities of hair shafts
• coiling and twisting abnormalities
• extraneous matter on hair shafts.
The hair shaft fracture group of abnormalities is the most important because it may lead to alopecia. Sometimes, however, these abnormalities occur sporadically or intermittently, 516 involving only isolated hairs as an incidental phenomenon. This is particularly likely to occur in those who subject their hair to physical or chemical trauma. More than one type of fracture may be present in these cases. 517 The following types of fractures will be considered:
• trichorrhexis nodosa
• trichoschisis
• trichoclasis
• trichorrhexis invaginata
• tapered fracture
• trichoptilosis
• trichoteiromania
• trichotemnomania.
Trichorrhexis nodosa is characterized by one or more small, beaded swellings along the hair shaft, corresponding to sites that fracture easily. Scalp hair is most often involved although the genital region may also be affected. 518 Trichorrhexis nodosa may be generalized or localized. 519 Alopecia may result because the hairs fracture easily.
The basic cause of trichorrhexis nodosa is prolonged mechanical trauma or chemical insults, although a contributing factor in some instances is an inherent weakness of the hair shaft. This weakness may result from a specific pilar dystrophy such as pili torti, monilethrix or trichorrhexis invaginata, or from an inborn error of metabolism affecting the hair such as citrullinemia (OMIM 2157000), 520 arginosuccinic aminoaciduria (OMIM 207900), 521 Menkes’ syndrome (OMIM 309400), 522 or trichothiodystrophy (see below).510.518.523.524.525. and 526. This latter group of abnormalities is quite rare but they usually form the basis of hereditary cases of trichorrhexis nodosa. 518 Trichorrhexis nodosa is also associated with other rare syndromes such as one that also includes intractable diarrhea of infancy, dysmorphism, and cirrhosis. 527 Neurocutaneous features may accompany the trichorrhexis nodosa syndrome (OMIM 275550).
Trichothiodystrophy (OMIM 601675) refers to a rare group of autosomal recessive disorders that have in common short brittle hair with a sulfur content less than 50% of normal.518.528.529.530.531. and 532. This results from a deficiency of the sulfur-containing aminoacid cystine in the cuticle and cortex.533.534. and 535. A defect in excision repair of ultraviolet damage in fibroblasts has been detected in many patients. Unlike xeroderma pigmentosum, in which this defect also occurs, there is no increase in skin cancer.536. and 537. Most patients exhibit mutations on the two alleles of the XPD (ERCC2) gene, mapped to 19q13.2, although rarely a mutated XPB (ERCC3) gene, mapped to 2q21, or TTDA gene may be involved.538. and 539. Further information is provided in an excellent review by Itin and colleagues. 530 Trichothiodystrophy is often associated with brittle hair, impaired intelligence, decreased fertility and short stature (BIDS syndrome – OMIM 234050), sometimes combined with ichthyosis (IBIDS syndrome),533. and 540. osteosclerosis (SIBIDS syndrome), 541or photosensitivity (PIBIDS syndrome).542. and 543. It has been suggested, and confirmed in mutant (TTD) mice, that the neurological features seen in some of these related syndromes are due to thyroid hormone deficiency resulting from XPD mutations. 538
The expanded areas of the hair shaft are composed of frayed cortical fibers which usually remain attached. 517 This appearance has been likened to the splayed bristles of two paint brushes (or brooms) thrust into one another (Fig. 15.11). 528 The cuticular cells become disrupted prior to this splaying of the cortical fibers.
Trichorrhexis nodosa with its characteristic fracturing of the hair shaft.
In black people, trauma-related cases of trichorrhexis nodosa usually affect the proximal part of the hair shaft, whereas in white and Oriental races the distal part is more often affected. 503
In those individuals with underlying trichothiodystrophy striking bright and dark bands are seen with polarized light (tiger-tail appearance).531.532.540.542. and 544. Lesions resembling trichorrhexis nodosa and trichoschisis may be present. 545 On scanning electron microscopy, the cuticle scales are often damaged or absent and there may be abnormal ridging of the surface.
Trichoschisis is a clean transverse fracture of the hair shaft through the cuticle and cortex. 503 It is usually seen in the brittle hair associated with trichothiodystrophy (see above).
Trichoschisis involves a clean transverse break in the shaft (Fig. 15.12). 503
Trichoschisis. There is a clean break in the shaft.
There is a transverse or oblique fracture of the shaft with irregular borders and a cuticle which is partly intact. 503 As such it resembles a greenstick fracture. 503 It does not indicate any specific underlying systemic disease, but rather it may follow trauma to the hair or be associated with pili torti, monilethrix, or other hair shaft abnormalities (see below).
Trichorrhexis invaginata (bamboo hair) is a rare but unique abnormality of the hair shaft in which there are nodose swellings that give the hair an appearance reminiscent of a bamboo stem. 546 The scalp hair is usually short, dull and friable and the eyebrows and eyelashes may be sparse. 528 It is one of the hair anomalies associated with Netherton’s syndrome (OMIM 256500), an autosomal recessive disorder in which there is also ichthyosis linearis circumflexa or some other ichthyosiform dermatosis (see p. 253).537. and 546. This hair shaft anomaly is seen less characteristically as a sporadic change following trauma or in association with other hair shaft abnormalities.503. and 546.
Trichorrhexis invaginata may result from a transient defect of keratinization of the hair shaft due to incomplete cystine linkages, leading to softness of the cortex at the point of disruption. 546
There is a cup-like expansion of the proximal part of the hair shaft which surrounds the club-shaped distal segment in the manner of a ball and socket joint. 503 If only the proximal half of the invaginate node is present, the appearances have been described as ‘golf-tee’ hairs. 547
Transmission electron microscopy shows cleavages and electron-dense depositions in the cortex. 546
Trichoptilosis refers to longitudinal splitting or fraying of the distal part of the hair shaft as a result of persistent trauma. 548 It results from separation of the longitudinal cortical fibers following loss of the cuticle from wear and tear. 503 A rare variant with the split in the center of the hair and reconstitution of the shaft distal to this has been reported.549. and 550. Other hair shaft abnormalities may also be present.
This factitious disorder is characterized by hair loss resulting from an obsessive-compulsive habit of cutting the hair with scissors or with a razor. Despite the alopecia, all infundibula are filled with a hair shaft. 552
This group of hair shaft abnormalities is characterized by various morphological irregularities in the hair. A common change, which is sometimes classified as a discrete abnormality, is longitudinal grooving of the hair. It is usually an isolated phenomenon of no clinical importance, although rarely it is widespread and associated with a form of congenital hypotrichosis or with trichothiodystrophy. 503 It will not be considered further. Enlargement of the hair shaft (trichomegaly) is discussed in this section.
Included in this group are the following entities:
• pili canaliculati et trianguli
• pili bifurcati
• pili multigemini
• trichostasis spinulosa
• pili annulati
• monilethrix
• tapered hairs
• bubble hair
• trichomegaly.
Each of these entities will be considered in turn.
Pili canaliculati et trianguli (pili canaliculi – OMIM 191480), a rare disorder of the hair shaft, is also known as the uncombable hair syndrome,553. and 554. cheveux incoiffables, 555 and the spun-glass hair syndrome.556.557. and 558. The hair is drier, glossier and lighter and it is unmanageable in that it does not lie flat when combed.559. and 560. It may be sparse. 561 The condition derives its name from the longitudinal canalicular depression in one side of the shaft and its triangular or kidney shape in cross-section.555. and 559. For clinical change to be apparent, approximately 50% of hairs must be affected with this abnormality. 562 It may result from a disorder of keratinization of the hair. 510 This hair shaft abnormality has been reported in patients with ectodermal dysplasia.563. and 564. This has been called Bork syndrome (OMIM 191482).
Straight hair nevus, a localized disorder in which the involved hairs are short and straight, in contrast to the usual woolly hair of black people, in whom this condition has been described, has been regarded as a localized form of uncombable hair. 565 However, it should be noted that in straight hair nevus there may be an associated epidermal nevus; furthermore, the hairs are normal in cross-section, in contrast to pili canaliculati et trianguli. 566 It has also followed the use of interferon-α and ribavirin in the treatment of hepatitis C infection. 567
The hairs appear normal on light microscopy. 557 Under polarized light, however, they have a diagnostic homogeneous band on one edge. 557 Under stereomicroscopy the grooves are easily seen. Paraffin-blocked hairs have a triangular or kidney-shaped appearance on transverse section. 557 The shape is confirmed by scanning electron microscopy, which also shows the longitudinal depression of the shaft resembling a canal.528. and 557. About 30% of hairs in some patients have torsions. 568
There are ultrastructural changes in the inner root sheath consisting of tonofilament-desmosomal detachment and tonofilament clumping within inner root sheath cells. 569
In the condition known as pili bifurcati, hairs show intermittent bifurcations of the shaft which subsequently rejoin further along the shaft to form a normal structure. 570 Unlike trichoptilosis, which it superficially resembles, each ramus of the bifurcated segments is invested by its own cuticle. 570 This abnormality has been regarded as a restricted form of pili multigemini. 503
Pili multigemini is a rare malformation of the pilary apparatus associated with the emergence of multiple hairs from a follicular canal which in turn is composed of as many papillae as there are hairs.571. and 572. These multigeminate follicles may arise on the face or the scalp. It differs from tufted-hair folliculitis in which distinctive tufts of multiple hairs emerge from a single follicular orifice into which several complete follicles open (see p. 430).
Trichostasis spinulosa presents either as asymptomatic, comedone-like lesions on the nose573 or as mildly pruritic hyperkeratotic papules on the upper trunk or arms.503.574.575. and 576. With a hand lens, multiple vellus hairs can sometimes be seen protruding from the patulous follicles. There is retention of telogen hairs within the follicles, although the reason for this is unknown. 574 Widespread trichostasis spinulosa has been reported in a patient on hemodialysis for chronic renal failure. 577 There is also a possible association with the prolonged topical application of a corticosteroid cream. 578
Multiple hairs are enveloped in a keratinous sheath within a dilated hair follicle. The keratin plug may protrude above the skin surface. There is only one hair matrix and papilla at the base of the follicle, 503 in contrast to pili multigemini. Sometimes there is mild perifollicular inflammation.
The condition of pili annulati (ringed hairs – OMIM 180600) is a rare, familial (autosomal dominant) or sporadic anomaly in which there are alternating light and dark bands along the shaft, when viewed by reflected light.526.579. and 580. Axillary hair is occasionally affected. An association with alopecia areata has been reported. 581 In one case, there was clinical disappearance of the disorder in the regrown hair following an episode of alopecia areata, although banding was still present in 20% of the hairs on light microscopy. 582
The light bands are due to clusters of abnormal, air-filled cavities which appear to result from insufficient production of the interfibrillar matrix.579. and 583. Various weathering patterns may be seen in involved hair shafts. 584
The term ‘pseudopili annulati’ refers to the presence of light and dark bands when slightly flattened or twisted hair is examined under reflected light.585. and 586. It is thought to be a variant of normal hair and to have no clinical significance. 503
The alternating light and dark bands occur approximately every 0.5 mm along the shaft when viewed by reflected light.583. and 587. The periodic bands become less frequent distally in the hair shaft. 588 Features of weathering are sometimes present. 588 Scanning electron microscopy reveals the presence of many small holes within the cortex as well as an irregular arrangement of the cuticular scales. 583 Cytokeratin expression is the same as normal hair. 589 Electron microscopy of the associated hair follicles shows a reduplicated lamina densa in the region of the root bulb. 590
In monilethrix (OMIM 158000) the hairs have a beaded or moniliform appearance as a result of a periodic decrease in the diameter of the hair.591. and 592. Inheritance is usually as an autosomal dominant trait with high gene penetrance but variable expressivity (see below). 503
The hair is susceptible to fracture at the narrower internodal regions, leading to short hair and hair loss. 593 The occipital region is usually involved soon after birth and the affected area slowly extends. 510 Other hairy areas may also be involved. Some improvement occurs with age and occasionally there is spontaneous remission at puberty. 528
The defect leading to monilethrix may result from a periodic dysfunction of the hair matrix.591.594. and 595. Abnormalities also exist in the inner root sheath adjacent to the zones of abnormal shaft thinning. Transmission electron microscopy has shown an abnormal cortex with areas of homogeneous non-fibrillar material and a deviated axis of some microfibrils. 596
The gene responsible for monilethrix maps to the region on chromosome 12 (12q13) containing the type II keratin cluster, which includes the basic type II trichocyte keratins.597. and 598. The defect may involve one of three keratin genes KRTHB6, KRTHB1, and KRTHB3.599. and 600. Several different mutations have been found.601. and 602. Nail defects appear common with KRTHB1 defects. 600 Monilethrix may be associated with keratosis pilaris, and with various ectodermal anomalies. These other syndromes are not well characterized. 603
Pseudomonilethrix (OMIM 177750) is characterized by irregularly placed nodes at irregular intervals along the hair shaft. It may be an autosomal dominant disorder producing hypotrichosis of the entire scalp, or just the occipital area, an acquired condition associated with various hair fragility disorders, and an iatrogenic condition. 604 The latter form may be the result of the compression of normal or fragile hairs between glass slides, prior to their microscopic examination. 605
The elliptical nodes of monilethrix, which are 0.7–1 mm apart, are separated by tapered internodes lacking a medulla (Fig. 15.13). 510 Scanning electron microscopy shows weathering changes with loss of cuticular cells and the presence of longitudinal grooves on the internodal shaft.503. and 591. The distal end of the hair shaft may show no beading; the changes are best seen in the proximal shaft. 606
Monilethrix. The tapered internodal regions lack a medulla.
Fractures and trichorrhexis nodosa may also be present.
Tapered hairs can arise in the same way as tapered fractures and they may also occur in association with other abnormalities of the hair shaft. 503 Several distinct variants have been described. The Pohl–Pinkus mark is an isolated narrowing of the hair shaft which coincides with a surgical operation or some other traumatic episode. 503 This narrowing is not as abrupt in the bayonet hair, which may possibly be a form of the Pohl–Pinkus mark. 503 Newly growing anagen hairs often have a tapered, hypopigmented top.
Bubble hair is a rare abnormality characterized by a large cavity in the shaft on scanning electron microscopy and an unusual ‘bubble’ appearance on light microscopy. 607 It presents with a localized area of brittle, easily broken hairs on the scalp. 608 The abnormality can be reproduced by heat, suggesting that hair dryers that overheat may be responsible.454.609.610. and 611.
Trichomegaly (OMIM 190330) refers to an enlargement and hypertrichosis of the eyelashes. It may be associated with more generalized hypertrichosis or with involvement of the eyebrows as well. There is a congenital and an acquired form. Interest in this condition has followed its association with various drugs such as interferon-α 2a and 2b, topiramate, cyclosporine, latanoprost, and the epidermal growth factor receptor (EGFR) inhibitor gefitinib.140.612. and 613. A variant associated with mental retardation and retinal degeneration (OMIM 275400) also occurs.
As the heading suggests, the hair shafts in this group of disorders adopt various configurations. 503 The following are involved:
• pili torti
• woolly hair
• acquired progressive kinking
• curly hair
• trichonodosis
• circle and rolled hair.
The condition of pili torti is the most important member of this group, while trichonodosis and circle hairs are of little consequence.
Pili torti (OMIM 261900) result from a structural defect in which the hair shaft is twisted on its axis at irregular intervals, with flattening of the hair at the sites of twisting. 614 This leads to increased fragility, particularly in areas subjected to trauma. 512 There are several clinical settings in which pili torti can occur. 503
The rare congenital (Ronchese) type presents at birth or soon after, with a localized area of alopecia or short hair which gradually spreads. 503 Sites other than the scalp may be affected. Pili torti may occur alone or in association with other syndromes, particularly of ectodermal type. 511 These include Bazex’s, Crandall’s, and Bjornstad’s syndromes615. and 616. as well as hypohidrotic ectodermal dysplasia. 512 They also occur in citrullinemia (OMIM 215700) 614 and in Menkes’ kinky hair syndrome.510. and 528. Bjornstad’s syndrome (OMIM 262000) combines pili torti with congenital hearing loss.617. and 618. The responsible gene maps to chromosome 2q34–q36. There is a mutation in the BSC1L gene, which encodes an ATPase required for the assembly of a mitochondrial complex. 520 Crandall’s syndrome combines pili torti, hearing loss, hypogonadism, and rarely, mental retardation. 520 In Menkes’ syndrome (OMIM 309400) the hair may show defects other than pili torti, including trichorrhexis nodosa, trichoclasis, and irregular twisting. 619 The gene maps to chromosome Xq13.
Postpubertal onset has also been recorded (Beare type). 512 Involvement of multiple hair-bearing sites and mental retardation are usually features of this variant. An acquired form of pili torti has been described as a result of trauma, associated with cicatricial alopecia, following the use of synthetic retinoids (isotretinoin), 620 and on the abdomen and thighs of hirsute males and females. 621 It has also been reported in anorexia nervosa. 622 Pili torti of early onset may improve with age.
‘Corkscrew’ hairs, an exaggeration of pili torti, have been reported in patients with ectodermal dysplasia.623. and 624. The presence of a longitudinal groove on the hair shaft has led to ‘corkscrew’ hairs being called pili torti et canaliculi. 624 This abnormality can also be seen in hereditary congenital hypotrichosis of Marie–Unna (see p. 420).
The twisting of the shaft is easily appreciated on light microscopy (Fig. 15.14). Fractures and trichorrhexis nodosa are sometimes present as well. 593Corkscrew hairs combine torsion and longitudinal grooving.
Pili torti. Twisting of the hair shaft is present.
Woolly hair is very curly hair that is difficult to style. It is normal in most black races but in white races it occurs in several different clinical settings.503.526.625. and 626. These include an autosomal dominant form (OMIM 194300) which affects the entire scalp (the hereditary type) for which no gene has been elucidated, an autosomal recessive form (the familial type – OMIM 278150) due to a mutation in the PKRY5 gene at 13q14.12–q14.2, a diffuse partial form where shorter, finer, curly hair is interspersed with normal hair, 625 and a well-demarcated localized form (woolly hair nevus) which may be associated with an ipsilateral epidermal nevus.627.628.629.630. and 631. Acquired progressive kinking of the hair (see below) is sometimes included as a variant of woolly hair. 510 Woolly hair has been reported in association with loose anagen hair, 632 hair-shaft fragility, 633 and skin fragility (OMIM 607655) due to a mutation in the desmoplakin gene (see p. 125). Woolly hair has also been associated with hypotrichosis, an everted lip and malformation of the ear (OMIM 278200), and several ectodermal dysplasias, usually including palmoplantar keratoderma as well.634. and 635. Specific associations include Naxos disease (OMIM 601214) – see p. 258, Noonan syndrome (OMIM 163950), cardiofaciocutaneous syndrome (OMIM 115150), and keratosis pilaris (OMIM 604093) and its variant ulerythema ophryogenes (see p. 433). 636
The hairs are usually normal on light microscopy, although on cross-section the shaft diameter is sometimes reduced. 503 In woolly hair nevus the hairs are more oval on cross-section than normal hairs; 625 a case with triangular hairs has been reported. 627 The follicles may be somewhat curved in woolly hair nevus.
Acquired progressive kinking of the hair shaft is rare. It is sometimes considered to be a variant of woolly hair, but is best regarded as a distinct entity on the basis of its onset at or after puberty, the involvement of certain regions of the scalp rather than the entire scalp, and the tendency for affected hair to resemble pubic hair both in texture and color.637.638.639. and 640. Acquired progressive kinking of the hair tends to occur in males who subsequently develop a male pattern alopecia of fairly rapid onset.637.641.642. and 643. ‘Whisker hair’, which occurs not uncommonly about the ears, is probably a variant.503.637.643. and 644.
Curly hair, in which there are large loose spiral locks, can be seen in many genetic syndromes including trichodentoosseous (TDO) syndrome (OMIM 190320), 539 Costello’s syndrome (OMIM 218040), CHAND (curly hair, ankyloblepharon, and nail dysplasia) syndrome (OMIM 214350), and Noonan’s syndrome (OMIM 163950). 520 The TDO syndrome is due to a mutation in the DLX3 gene on chromosome 17q21. It is a homeobox gene important for embryonic development. 520
Trichonodosis (knotted hair) is usually an incidental finding in individuals with various lengths and types of scalp hair, particularly those with curly or kinky hair.646. and 647. Knots are very common in curly African hair, leading to fracturing and breaking when combed. African hair length is less than that of white people, possibly because of the hair loss associated with the combing of knotted hair. 648 There may be a single or a double knot. Various hair shaft abnormalities of a secondary nature may be present in and adjacent to the knots. 503
Multiple large knots involving body hairs have been reported. The hairs show an unusual twisting and matting. 649
Hair matting is a rare acquired condition characterized by irreversible tangling of hair. It has many causes other than trichonodosis. They include hair density and coiling, chemical and physical treatments to the hair, including the use of conditioners, 650 frequent combing, 651 and neglect.652. and 653. The original term plica neuropathica is sometimes used for this condition.654. and 655.Plica polonica refers to the same phenomenon. 656
Circle hair presents as a black circle related to hair follicles as the result of a hair shaft becoming coiled into a circle under a thin transparent roof of stratum corneum.657. and 658. The cause of this abnormality is unknown but it may be seen in middle-aged men on the back, abdomen, and thighs. 657 The case reported as pili migrans has some similarities (see p. 411).
Rolled hair (the term is sometimes used interchangeably with circle hair) refers to a common disorder of hair growth in which the hairs are irregularly coiled but do not form a perfect circle. 659 It is usually associated with some other disorder such as keratosis pilaris.
Whorled hair, in which multiple whorls are present, is probably a related disorder. 660 This phenomenon may be associated with anomalies in brain development. 660
In circle hair there is no associated follicular abnormality or inflammatory component. 659
Hair shafts may be colonized by fungi (tinea capitis and piedra), bacteria (trichomycosis axillaris), and the eggs (nits) of the lice causing pediculosis capitis. 503 Casts resembling nits (hair casts, pseudo-nits) may occur in association with various scaly dermatoses of the scalp or as a rare, idiopathic phenomenon. Deposits such as lacquer, paint, and glue form another category of extraneous matter.
In tinea capitis, fungal elements may be found on the surface of the hair shaft (ectothrix) or within the substance of the hair (endothrix). 503 In both cases the affected hairs are fragile and break near the skin surface.
The condition known as piedra occurs in two forms, white piedra and black piedra. 503 They are characterized by the formation of minute concretions on the affected hair (the Spanish word piedra means stone).
White piedra (trichosporonosis, trichosporosis)661. and 662. is a rare superficial infection of the terminal part of the hair caused by the yeast-like fungus Trichosporon beigelii (cutaneum). It occurs particularly in South America, parts of Europe, Japan, the Middle East, and the United States.663. and 664. There are numerous discrete or coalescing cream-colored nodules, just visible to the naked eye, forming sleeve-like concretions attached to the hair shaft.665. and 666. White piedra may affect hairs on the face, scalp, or scrotum. 665 Fracture of the hair shaft may result. A synergistic coryneform bacterial infection is sometimes present. 667
Black piedra, which is caused by the ascomycete Piedraia hortae, consists of gritty black nodules which are darker, firmer, and more adherent than those found in white piedra. 666 Black piedra is prevalent in tropical climates. A case of black piedra due to Trichosporon asahii has been reported. 668
The treatment of white piedra is an area of therapeutic frustration. 669 Shaving the hair is one recommended treatment, but this is not acceptable in some societies. Itraconazole has been used successfully in one series with a low failure rate, but with some recurrences on cessation of treatment. 669 Antifungal shampoos have also been used, alone, 667 or in combination with an oral azole antifungal agent. 670
In white piedra, a potassium hydroxide preparation of a hair shows that the concretions are composed of numerous fungal arthrospores in compact masses encasing the hair shaft. 666 In one case white piedra spores were packed inside empty nits from an accompanying infestation with Pediculosis capitis. 671 In black piedra, the nodules are composed of brown hyphae with ovoid asci containing 2–8 ascospores. 666 The fungus shows strong keratinolytic activity with the capacity to destroy both the cuticle and the hair cortex. 672
In trichomycosis axillaris, there are tiny, cream to yellow nodules attached to axillary or pubic hair (Fig. 15.15). 503 It is not a mycosis but the result of infection by a species of Corynebacterium.
Trichomycosis. (A) Small pale nodules are attached to some of the hair shafts. (B) Microscopy of an involved hair shaft shows the attached extraneous matter.
Nits are small white to brown ovoid structures attached to the hair shaft. 503 They are the eggs of the lice responsible for pediculosis capitis (see p. 658).
The egg lies to one side of the hair shaft, to which it is attached by a sheath that envelops both the shaft and the base of the egg. 503
Hair casts (peripilar casts, pseudo-nits) are firmish, yellow-white concretions, 3–7 mm long, ensheathing hairs and movable along them. 673 Two types of hair casts exist.674.675.676.677. and 678. The more common type (parakeratotic hair cast) is associated with various inflammatory scalp disorders such as psoriasis, seborrheic dermatitis, and pityriasis capitis. 674 The second type (peripilar keratin cast), which is quite uncommon, occurs predominantly in female children without any underlying disease as a diffuse disorder of scalp hair. 675 Hair casts appear to be nothing more than portions of root sheath pulled out of the follicle by a hair shaft itself. 679 Tight plaiting of the hair, leading to local scalp ischemia and consequent damage to the root sheaths of the follicle, may be responsible for the formation of hair casts.676.677. and 678. Hair casts have also been associated with the use of a deodorant spray; 680 usually they cause small deposits (see below).
In both types of hair casts the follicular openings contain parakeratotic keratinous material which breaks off at intervals to form the hair casts. In casts associated with parakeratotic disorders it seems that only external sheath is present in the casts. In the uncommon peripilar casts, both inner and outer root sheaths are demonstrable on transverse section of the cast. Scanning electron microscopy has confirmed the presence of an inner, incomplete layer and an outer, thicker, but less compact layer. 679
There are several hundred disease states or events that may precipitate abnormal hair loss. As a consequence, any etiological classification of the alopecias is invariably composed of long lists of causative factors.683. and 684. From a clinical viewpoint, alopecias are usually divided into those that are patterned and those that diffusely involve the scalp. Further subclassification into scarring and non-scarring types is usually made. Scarring alopecias are almost invariably irreversible and are therefore of great clinical importance. Biopsies are not often taken from alopecias which are diffuse and non-scarring as the etiology is often apparent to the clinician or the alopecia is subclinical or not of cosmetic significance. Sellheyer and Bergfeld have recently published a useful histopathological review of the alopecias. 685
A more useful approach for the dermatopathologist is a classification based on the mechanisms involved in the hair loss. 686 This has some shortcomings in that our knowledge of these mechanisms is not complete, particularly in some of the congenital/hereditary alopecias. Furthermore, some of the early reports of this group lack histological descriptions of the skin and hair shafts. For this reason, the congenital/hereditary alopecias will be considered together until further knowledge allows a more accurate subdivision based on the mechanism involved.
The histological diagnosis of the alopecias is best made from transverse (horizontal) as opposed to the traditional vertical section (Table 15.1). This view has been challenged by Böer and Hoene. 687 Transverse (horizontal) sections allow all follicles in a biopsy to be visualized simultaneously.688.689. and 690. The diagnostic yield can be maximized if both vertical and transverse sections are utilized. 691 This latter view has been championed by Elston.692. and 693. Either one alone (vertical or horizontal) may also be satisfactory. 694
Lupus erythematosus
Lichen planopilaris (one-third of cases)
Lupus erythematosus*
Lichen planopilaris*
(*Both have lichenoid features)
Idiopathic scarring alopecia
Dissecting cellulitis of the scalp
Folliculitis decalvans
Acne keloidalis
Infectious folliculitis
Lupus erythematosus
Lichen planopilaris
Idiopathic scarring alopecia
Androgenetic alopecia
Alopecia areata (regrowth)
Alopecia areata
Lupus erythematosus
Androgenetic alopecia
Idiopathic scarring alopecia
Traction alopecia
In horizontal sections of a 4 mm punch biopsy about 33 terminal hairs will be present. 695 In the upper half of the dermis, hairs are arranged in follicular units containing two to four terminal hairs and often one or more vellus hairs. This subject is reviewed in the excellent monograph by Sperling. 695
The following classification of alopecias will be used in the account which follows:
• congenital/hereditary alopecias
• premature catagen/telogen
• premature telogen with anagen arrest
• vellus follicle formation
• anagen defluvium
• scarring alopecias
• hair shaft abnormalities (see p. 411).
Before discussing the various mechanisms of hair loss, brief mention will be made of the normal hair cycle.
The formation of hairs is a cyclical phenomenon which results from successive periods of growth, involution, and rest by hair follicles.696. and 697. In 2003, Stenn published a review of all aspects of the hair follicle and its molecular control. 698 Other papers have also been published on this topic. 699 The phase of active hair production is known as anagen. It lasts for a period of 2–6 years on the scalp, although the average duration is usually quoted as 1000 days. 503 At any one time, 85–90% of the 100 000 hair follicles on the scalp are in the anagen phase. There is regional variation in the duration of anagen. For example, anagen lasts for approximately 1 year in the beard region, while its duration in the axilla and pubic region is only a few months. 700 The length of a hair shaft is directly proportional to the length of the anagen phase. 698
The involutionary stage, catagen, is quite short, lasting for less than 2 weeks in each hair follicle on the scalp. There is very little regional variation in the duration of catagen, although in some animals this period may be as short as 24 hours. Approximately 1% of scalp follicles are in the catagen phase at any time. 685 In humans, the entry of follicles into catagen is a random process, in contrast to its synchronous onset in animals (molting). Seasonal factors, including temperature and light intensity, play some role in precipitating molting in certain animals. In other animals and in humans, the factors that normally precipitate catagen are not known. 701 Recent studies have addressed this issue of the ‘hair cycle clock’.702.703. and 704. The use of transgenic mice is providing valuable information. 705
Transforming growth factor-β (TGF-β) is expressed immediately before catagen and tumor necrosis factor-β during catagen.702. and 706. TGF-β plays an important role in keratinocyte apoptosis during catagen and it facilitates shrinkage/contraction of the companion layer of the proximal and mid follicle. 707 Glial cell line-derived neurotrophic factor is a member of the TGF-β superfamily.708. and 709. It too is differentially expressed in different stages of the hair follicle cycle. 709 The levels of c-myc, c-myb, bax, and c-jun change immediately before or during early catagen, suggesting that they play a role in the induction of apoptosis. 702 The oncogene c-myc has the ability to induce both cell growth and apoptosis, depending on environmental conditions. 710 There are two clusters of c-myc expressing cells in anagen follicles.711. and 712. A reduction in bcl-2 expression also occurs during catagen. 713 The expression of heat shock protein-27 is weak in both catagen and telogen. 714 These various cytokines may result from cyclic activation of the sonic hedgehog pathway. Catagen follows a set period of anagen which is presumably genetically determined in some way for each particular region. The mechanism by which hair follicles shorten during catagen was an enigma for a long time. It was in part attributed to the cessation of mitoses in the hair matrix and also to ‘collapse’, ‘regression’, ‘disintegration’, and ‘involution’ of the lower follicle. 715 It is now known that massive cell loss by apoptosis is the mechanism responsible for catagen involution.701.715. and 716. The apoptotic fragments are quickly phagocytosed by adjacent cells in the lower follicle and by macrophages. 701 With progressive retraction of the follicle resulting from this cell loss, there is wrinkling and thickening of the fibrous root sheath.
The resting phase, telogen, lasts for approximately 3–4 months. During this period, there is no active hair production. 700 At any one time, approximately 10–15% of scalp follicles are in this phase. Often included as part of telogen is the lag phase (kenogen), the true resting period of the hair follicle.717. and 718. This is followed by regrowth of the hair follicle and a new anagen phase. The telogen hair (club hair) is extruded and shed at this time. The cornified cells of the outer sheath in catagen, the cornified cells of the inner sheath, and of the hair combine to create the appearance of a club at the base of a telogen hair. 719 Exogen and teloptosis are two terms that have been proposed for the process of shedding of the club hair. 718 The club hair is not pushed from the follicle by the new anagen hair as once thought. There is a loss of adhesion between cells of the club hair and those of its epithelial envelope. 718 Synchronized teloptosis (exogen) may account for the increased shedding in telogen effluvium.
Each stage of the hair cycle has a characteristic morphological appearance. 696
Catagen follicles are characterized by loss of mitotic activity in the matrix and the cessation of pigment production by melanocytes in the hair bulb. Scattered apoptotic cells develop in the outer root sheath, an easily recognizable sign of catagen (Fig. 15.16). 715 Some melanocytes also undergo apoptosis. 720 The inner root sheath disappears and there is progressive thickening and corrugation of the fibrous root sheath. The lower end of the follicle gradually retracts upwards with a trailing connective tissue streamer beneath it. It is possible that Langerhans cells play a role in the removal of melanin from the hair bulb in early catagen. 721
Early catagen follicle. Note the numerous apoptotic cells. (H & E)
Telogen follicles consist of a short protrusion of basaloid, undifferentiated cells below the epithelial sac which surrounds the club hair. This is situated not far below the entrance of the sebaceous duct. The telogen hair, if plucked, has a short, club-shaped root that lacks root sheaths and a keratogenous zone (Fig. 15.17). There is also depigmentation of the proximal part of the shaft.503. and 700. The transition from anagen to telogen is marked by down-regulation of hair cortex-specific keratins and the appearance of hK14 in the epithelial sac to which the telogen hair fiber is anchored. 722
Telogen hairs with a short club-shaped root.
Anagen growth recapitulates to some extent the changes present in the original development of the follicle. 723 There is increased mitotic activity in the germinal cells at the base of the telogen follicle. This ball of cells extends downward, partly enclosing the dermal papilla. 724 Both descend into the dermis along the path of the connective tissue streamer that formed during the previous catagen phase. The matrix cells of the new anagen bulb form a new inner root sheath and hair. 724 Melanocytes lining the papillae form melanin again. Only anagen hairs show CD34 immunoreactivity with CD34-positive cells located in the outer root sheath below the attachment zone of the arrector pili muscle. 725 CK15-positive cells are located in the outer root sheath above the attachment zone. 725 CD1d is also expressed in anagen but not the other stages of the cycle. 726 Syndecan-1 is another substance that is differentially expressed during the hair cycle. This proteoglycan is strongly expressed in the anagen phase outer root sheath and in the dermal papilla but expression diminishes with involution of the hair follicle. 727 Plucked anagen hairs have long indented roots with intact inner and outer root sheaths and are fully pigmented. 700 Slowly plucked anagen roots are bare and show ruffling of the cuticle over a special segment of the root: quickly plucked anagen roots are usually covered by various sheath remnants, hence ruffling occurs only rarely. 728
An attempt has been made to quantify the number of hairs lost daily. Based on the number of scalp hairs and the duration of anagen, a theoretical figure of 100 shed hairs per day is obtained. A more practical method of establishing a normal baseline of hairs shed and standardizing the process is the 60-second hair count. 729 In this method hair is combed with a standard comb for 60 seconds onto a towel or pillowcase and the hair counted. The mean was 10.3 hairs in one study, but this figure may be artificially low as the hair was shampooed daily for the 3 days preceding the count. 729
The rare alopecias of the congenital/hereditary clinical grouping are considered together because the mechanisms involved in the pathogenesis of the hair loss are not known for some of the conditions. 724 Furthermore, biopsies have not been carried out on some of the entities listed, while in other instances the biopsy findings have not been consistent from one report to another. Several different clinical groups of congenital/hereditary alopecias (hypotrichosis) are usually recognized:528. and 730.
• alopecias without associated defects
• alopecias in association with ectodermal dysplasia
• alopecias as a characteristic or inconstant feature of a named syndrome.
Alopecia or hypotrichosis occurs without any associated defect in alopecia universalis congenita, hereditary hypotrichosis (Marie–Unna type) and atrichia with papular lesions, and in keratosis pilaris atrophicans. These conditions are considered further below. Localized alopecia, possibly occurring as a nevoid state, has been reported. 731 Another localized form of alopecia, temporal triangular alopecia, involves the presence of vellus follicles and is discussed on page 427.
Alopecia is a characteristic feature of one subgroup of the ectodermal dysplasias, a heterogeneous group of congenital diseases involving the epidermis and at least one appendage. Absence or hypoplasia of hair follicles has been recorded in some of these rare syndromes, 732 while in others no detailed studies have been made. The ectodermal dysplasias have been discussed on page 276.
There is a long list of rare syndromes in which alopecia is a characteristic or inconstant feature.733. and 734. Skeletal abnormalities are present in one subgroup.528. and 735. These have been reviewed elsewhere. 528 Little is known about the mechanism of the alopecia in this group. One entity, the Hallermann–Streiff syndrome, will be discussed briefly below because something is known of its pathology.
Alopecia universalis congenita (alopecia congenitalis, universal congenital alopecia – OMIM 203655) refers to cases of congenital alopecia without associated defects.528. and 736. It is a heterogeneous group. Hair loss occurs at birth or shortly after in one subgroup with autosomal recessive inheritance, while in those with one form of autosomal dominant inheritance the hair is normal until mid childhood.737. and 738. The autosomal recessive form is linked to the human hairless gene (HR) at 8p21.2.739. and 740. Misdiagnosis as alopecia areata occurs. 741 Another autosomal dominant form has been called hypotrichosis simplex (OMIM 146520). 742 It is of early onset and without associated abnormalities. The gene for this condition, the corneodesmosin (CDSN) gene, has been mapped to chromosome 6p21.3.743.744. and 745. Autosomal recessive transmission and a sporadic case have also been reported. 746 The variant linked to a short anagen phase has now been reclassified as short anagen syndrome (see p. 420). 747
Hypotrichosis with juvenile macular dystrophy (OMIM 601553) is a rare autosomal recessive disorder characterized by sparse and short hair and progressive degeneration of the retinal pigment epithelium leading to blindness by the second decade of life. It is due to a mutation in CDH3, a gene encoding P-cadherin, a major component of adherens junctions, located at 16q22.1. 748
A related disorder, also due to a CDH3 mutation, also causes ectodermal dysplasia, ectrodactyly, and macular dystrophy – EEM (OMIM 225280). Hypotrichosis and hypodontia are also present. 748
Other hypotrichosis syndromes are: an autosomal recessive localized form (OMIM 607903) due to a mutation in the desmoglein 4 (DSG4) gene on chromosome 18q12; another localized form (OMIM 611452) due to a mutation in the P2RYS gene at 13q14.12–q14.2; 749 a total hypotrichosis caused by a mutation in the lipase H (LIPH) gene (OMIM 604379) on 3q27–q28; 750 a hypotrichosis–lymphedema–telangiectasia (OMIM 607823) form due to a mutation in the SOX18 gene at 20q13.33; 751 and focal hypotrichosis occurring in Gomez–Lopez–Hernandez syndrome (OMIM 601853), also known as cerebello-trigeminal-dermal dysplasia. 752
Hair follicles are hypoplastic and reduced in number. 528 In one report, they were described as being of vellus type. 753 In one of the dominant forms, follicles are said to be normal in number initially, but they fail progressively to re-enter anagen. 724 Small cystic remnants of the follicles lined by outer root sheath-like epithelium are often present in the dermis. 754 In hypotrichosis with juvenile macular dystrophy the appearances resemble chronic telogen effluvium. 755
Hereditary hypotrichosis (Marie–Unna type – OMIM 146550) presents with short, sparse hair at birth and hair growth in childhood that is coarse and wiry. 756 There is progressive loss of hair resembling androgenetic alopecia, commencing during adolescence. 528 It is an autosomal dominant condition associated with a defect in chromosomal region 8p21. One study mapped the gene to 8p21.3. 757 This is close to, but distinct from, the human hairless gene (HR) responsible for atrichia with papular lesions (see below).758.759. and 760. There appears to be genetic heterogeneity. 761
The association of Marie–Unna hypotrichosis with onycholysis and cleft lip/palate has been given the OMIM number of 609250. It is not related to the gene that causes Marie–Unna hypotrichosis.
There are no specific features apart from a mild to moderate perifollicular inflammatory reaction, although progressive destruction of hair follicles is the probable mechanism.528. and 762. Follicles are reduced in number. Milia, mild fibrosis, and perifollicular granulomas have been recorded.528. and 762.
Atrichia with papular lesions (OMIM 209500) is a rare disorder in which progressive shedding of scalp and body hair occurs in the first few months of life.763.764.765. and 766. The eyelashes are typically spared. Numerous small, milia-like cysts develop on the face, neck, scalp, and extremities in childhood and early adult life. 767 It is an autosomal recessive condition in which mutations occur in the human hairless gene (HR), a putative single zinc-finger transcription factor protein which has been mapped to chromosome 8p21.2.739.768. and 769. Numerous mutations have been described.770.771.772. and 773. Compound heterozygosity has also been reported. 774 Mutations in this gene are also responsible for alopecia congenitalis (universal congenital alopecia), which differs by having no papular lesions (see above).739. and 775.
Atrichia with papules also occurs in the clinical setting of vitamin D-dependent rickets type IIA (OMIM 277440), resulting from mutations in the vitamin D receptor (VDR) gene on chromosome 12q13.1.776.777.778. and 779. The clinical findings of the two types are strikingly similar.
The small follicular cysts resemble milia. They contain keratinous material, which is sometimes calcified, but there are no vellus hairs in the lumen. Scattered foreign body giant cells may be present around some of the cysts. In the scalp the infundibulum of the follicle is normally developed, although it often contains a keratin plug. There is a lack of development of the germinal end of the follicle, with no shaft formation. 780 A histological comparison of alopecias associated with vitamin D-dependent rickets and hairless gene mutations found striking similarities. 754
Keratosis pilaris atrophicans refers to a group of clinically related syndromes in which inflammatory keratosis pilaris leads to atrophic scarring (see p. 433). This condition is mentioned here because it is regarded as a congenital follicular dystrophy.
The Hallermann–Streiff syndrome (mandibulo-oculofacial dyscephaly – OMIM 234100) is a branchial arch syndrome which combines a characteristic bird-like facies with ocular abnormalities and alopecia, which may have an unusual sutural distribution on the scalp.781. and 782. Atrophic patches of skin, which may be limited to the areas of alopecia, also occur. 781 Most cases appear to occur as new mutations. 724
The trichorhinophalangeal syndrome (OMIM 190350) is a rare autosomal disorder with sparse and slow-growing hair, facial dysmorphism, and bone deformities. 783 It is due to mutations in the TRPS1 gene on chromosome 8q24. It encodes a zinc finger transcription factor. 784
Very little is known about the histological characteristics of the alopecia, although the atrophic areas are composed of loosely woven collagen. 724 The hair shafts show some cuticular weathering on scanning electron microscopy. 781 Circumferential grooving of the shaft has also been noted in some cases. 785
This recently described anomaly is characterized by ‘hair that never needs cutting’. It has probably been underreported. 747 There is short, fine scalp hair with normal body hair and eyelashes. 786 Only 24% of hairs were in anagen in one hair pull study. 786 A biopsy, with vertical and not horizontal sections, appeared unremarkable. Thai and Sinclair have reported a case with persistent synchronized scalp hair growth associated with short anagen duration. 787 A patient with two localized areas of short anagen (‘short anagen hair nevus’) responded to treatment with 5% topical minoxidil. 788
At any one time, approximately 10–15% of the hair follicles of the scalp are in the resting (telogen) phase and, because of its shorter duration, only a small number of follicles are in the preceding involutionary stage of catagen. Under certain circumstances an abnormal number of hair follicles are in the telogen phase. This results from the premature termination of anagen. 789 After a latent period of approximately 3 months from the onset of catagen/telogen, club hairs are lost, leading to thinning of the hair. 789 It is surprising how much hair can be lost before this thinning becomes noticeable. 789 A cyclical increase in telogen hairs has been reported in patients with severe dandruff in whom increased hair shedding and a slowly progressive alopecia may develop. 790
Numerous telogen follicles are found in telogen effluvium (see below), a condition which results from various stressful circumstances and from some drugs, such as heparin. 789 Catagen hairs are not usually found because such conditions are not biopsied until the hair loss becomes noticeable, some 3 months after the onset.
In trichotillomania (see below) and certain traumatic alopecias, the insult is usually continuous and, accordingly, catagen follicles are seen in addition to telogen ones. Catagen follicles are sometimes prominent at the rapidly advancing edge of a patch of alopecia areata.
In summary, catagen follicles are prominent in trichotillomania and related traumatic alopecias resulting from traction associated with hairstyles and the like. They are often seen at the edge of a patch of alopecia areata. Telogen follicles are prominent in telogen effluvium, in alopecia areata, and in a rare disorder with its onset in childhood, familial focal alopecia. 791 In this latter condition there is telogen arrest with prolonged persistence of telogen follicles, in contrast to the transient nature of the process in telogen effluvium. 791
Trichotillomania is a rare form of alopecia resulting from the deliberate, although at times unconscious, avulsion of hairs by patients who may be under psychosocial stress.792. and 793. In adults it is more common in women; in children there has been no sex predilection in some series. In children, eating the plucked hair may lead to the formation of trichobezoar (hair balls). 794 It has been claimed recently that the term ‘trichotillomania’ is outdated, pejorative, and offensive to patients. 795 The term ‘neuromechanical alopecia’ has been suggested as a replacement. 795
Although the crown and occipital scalp are primarily affected, other areas of the scalp, as well as the eyebrows, trunk and pubic areas, 796 may also be involved. Isolated involvement of the eyebrows and eyelashes has been reported.797. and 798. Similar features can result from traction of hair associated with hairstyles and from prolonged pressure. 799 Pressure appears to be involved in the occipital alopecia that occurs in children and some adults after surgery of prolonged duration.800. and 801. The term ‘traumatic alopecia’ can be applied to such cases, including trichotillomania.802. and 803. Clinical differentiation from alopecia areata can be difficult.
A related disorder involving the nails is called onychotillomania in which patients neurotically pick or injure their nails until they are permanently altered. 804
If trauma (such as traction) is repeated, prolonged and severe, then additional features, including scarring, will develop. This is best called traction alopecia with scarring, but it is also known as ‘hot comb’ alopecia and follicular degeneration syndrome (see p. 430). 805
The management of patients with trichotillomania involves psychiatric and support services beyond the scope of this book. Guidelines for the management of trichotillomania were published in 2002. 806 Traction alopecia is best managed by advice to the patient on the underlying mechanism of their alopecia.
The histological features are characteristic, but not all of the recognized features are present in every biopsy. There is a greater chance of observing them if multiple sections are examined. Horizontal sections also enhance the diagnostic rate, although most of the studies have been done on vertical sections. 695 The two most specific features are the presence of increased numbers of catagen hairs, associated usually with the presence of early and late anagen hairs, and the presence of empty hair ducts. 806 Bergfeld and colleagues believe that trichomalacia and pigmented casts (see below) are the major diagnostic criteria. 812 Other changes include dilated follicular infundibula which may contain melanin casts and keratin plugs, clefts around the lower end of hair follicles, distortion of the hair bulb with dissociation of cells in the hair matrix, the release of melanin pigment within the papilla and surrounding connective tissue sheaths, traumatized connective tissue sheaths, small areas of dermal hemorrhage and empty spaces in the sebaceous glands (Fig. 15.18). 808 The pigment casts may not be the result of hair manipulation but rather a reflection of the sudden termination of the anagen phase of the hair cycle. 801 Sometimes splitting of the hair shaft in a vertical orientation occurs with proteinaceous material and erythrocytes in this split. This has been called the ‘hamburger bun sign’. 813 Sometimes there is even extrusion of sebaceous lobules. Only a very sparse inflammatory infiltrate is present.
Trichotillomania. Melanin casts and keratin plugs are present in the dilated follicular infundibula. (H & E)
Telogen effluvium is an abnormality of hair cycling that results in excessive loss of telogen hairs. It has been regarded as a syndrome and as a non-specific reaction pattern, rather than as a disease sui generis.789.814.815. and 816. It is nevertheless a useful term to apply to those cases of diffuse hair loss in which various stressful circumstances precipitate the premature termination of anagen. It is one of the most common causes of diffuse hair loss. 817 Telogen effluvium can follow febrile illness, parturition, systemic illnesses, chronic infections (including HIV infection), 818 allergic contact dermatitis of the scalp, 819 air travelers’ ‘jet lag’, psychogenic illnesses, ‘crash diets’, iron deficiency,820. and 821. and sudden severe stress. 822 It may also be associated with an internal cancer, 686 cytotoxic drugs, 823 and with the eosinophilia-myalgia syndrome. 824 Loss of hair in the newborn is a physiological example of this process. 789 Exceptionally, drugs such as heparin, clofibrate, gentamicin, niacin (nicotinic acid), nitrofurantoin, salicylates, oral contraceptives, anticonvulsants, pramipexole, 825 excess vitamin A, and the antihypertensive agent minoxidil826 have been implicated in the etiology of telogen effluvium.689.827. and 828. Headington has defined five different functional types of telogen effluvium. 828
Telogen effluvium presents as a diffuse thinning of the scalp hair, although the hair loss is not always obvious clinically. Hair loss usually occurs about 3 months after the precipitative event. Sometimes this hair loss unmasks small areas of alopecia, of other causes, which had previously gone unnoticed.
In chronic telogen effluvium (defined as shedding that persists beyond 6 months) there is hair shedding of abrupt onset followed by a fluctuating course in which there is diffuse thinning all over the scalp, frequently accompanied by bitemporal recession.822. and 829. There is no frontoparietal hair loss and these women characteristically present with a full, thick head of hair. 830 It is more common in postmenopausal women, 831but it has been seen in men. 832 It must be distinguished from female pattern hair loss, which often has overlapping features.833. and 834. Both conditions may have trichodynia. 835 Hair shedding in this condition appears to be self-limiting.
A biopsy of the affected scalp will show a proportionately greater number of normal telogen follicles than usual. 685 The total number of hair follicles is normal. There is no inflammation in the dermis. An examination of plucked hairs will reveal telogen counts greater than 25%.
In horizontal sections of chronic telogen effluvium the terminal/vellus-like hair ratio (T : V) in one study was 9 : 1 compared to 1.9 : 1 in androgenetic alopecia. 829 At the mid-isthmus level a T : V of less than 4 : 1 is considered diagnostic of female pattern hair loss, whereas a ratio greater than 8 : 1 indicates chronic telogen effluvium. 830 The differentiation of chronic telogen effluvium from female pattern hair loss is considerably enhanced by the use of triple horizontal biopsies versus a single horizontal biopsy. 836 Inflammation is also more common in androgenetic alopecia than in chronic telogen effluvium. 829
Alopecia areata is the only type of hair loss in which the mechanism of premature telogen with anagen arrest applies. At the expanding edge, follicles in late catagen and telogen are characteristic findings, although in older lesions follicles in an arrested anagen phase are also present.
Alopecia areata (OMIM 104000) is a relatively common condition affecting individuals of any age, but particularly those between the ages of 15 and 40.837.838.839. and 840. Its incidence is 0.1–0.2%, 841 and the lifetime risk is approximately 2%. More than 4.5 million people in the United States are affected. 842 Although mild cases may escape clinical detection, alopecia areata usually has a sudden onset with the development of one or more discrete, asymptomatic patches of non-scarring hair loss on the scalp. 843 Exclamation mark hairs are found near the advancing margins. 843 The clinical course is variable. 844 There may be spontaneous remission, sometimes followed by exacerbations, or there may be relentless progression to involve the entire scalp (alopecia totalis) and, uncommonly, all body hair (alopecia universalis).845. and 846. Progression to alopecia totalis is more likely in children.847.848. and 849. In one study 7% of patients with alopecia areata progressed to alopecia totalis or universalis. 850 HLA-DR11, HLA-DR4, and HLA-DQ7 are significantly increased in frequency in patients with alopecia totalis/alopecia universalis in contrast to patients with patchy alopecia areata.851. and 852. Alopecia universalis may be a manifestation of the immune dysregulation, polyendocrinopathy, enteropathy, X-linked (IPEX) syndrome (OMIM 304790) due to a mutation in the FOXP3 gene at Xp11.23–q13.3. 853 It also occurs as a manifestation of Satoyoshi syndrome (OMIM 600705) in which there are intermittent painful muscle spasms and malabsorption. Other HLA profiles may be increased in some ethnic groups. 854
A family history of alopecia areata is present in 8–50% of affected individuals.837.847.855.856.857.858.859. and 860. Inheritance is polygenic, 861 but there appears to be an association with HLA class II genes.768.862.863. and 864. More specific genetic associations have now been reported. It has been associated with a genetic variant in the protein tyrosine phosphatase nonreceptor 22 (PTPN22) gene. 865 In another study four susceptibility loci were found on chromosomes 6, 10, 16, and 18. 842 The locus on chromosome 6 was in the region of the major histocompatibility complex locus. 842 The chromosome 16 locus has been given an OMIM number of 610753, a gene map locus of 16q11–q22 and the title of alopecia areata type 2. There is a 55% concordance rate in identical twins. 866 Congenital alopecia areata is exceedingly rare.867. and 868.
Regeneration is heralded by the development of fine white or tan hair. 843 Most times the depigmented hair regrowth lasts one hair cycle, but persistent depigmented hair does occur. 869 In one such case only pigmented hairs were lost in the initial hair loss phase leading to completely white hair after treatment and regrowth. 870 In another case, graying hairs were spared. 871
There are conflicting data on the clinical associations of alopecia areata. Many reports have documented an increased incidence of autoimmune diseases such as Hashimoto’s thyroiditis, Addison’s disease, idiopathic primary hypophysitis, 872 thrombocytopenia, 873 vitiligo, 874 and lupus erythematosus, but not others.843.845. and 875. Children with alopecia areata have an increased family history of autoimmunity. 876 Autoantibodies to various thyroid antigens,877.878. and 879. gastric parietal cells, 855 and smooth muscle880 have been reported, 881 although not all of these findings have been confirmed by others. 882 There are also conflicting results on the various cell-mediated functions in alopecia areata, but this may in part reflect the different techniques that have been used and the heterogeneous nature of this condition.879. and 883. Other clinical associations have included atopic states,858. and 884. Down syndrome,885. and 886. Turner’s syndrome, 887 the use of rifampin (rifampicin), 888 efalizumab, 889 adalimumab, 890 infliximab,889. and 891. cyclosporine, 892 etanercept, 893 and interferon alpha, 894 hypomagnesemia, 895 HIV infection, 848 psychiatric comorbidity, 896 CMV infection, 866 Epstein–Barr virus infection, 897 pili annulati, 898 the regression of cutaneous melanoma, 899 the sparing of areas with psoriasis, 900 and with a congenital nevus, 901 and following vasectomy. 902 Various nail changes have been reported in 10–25% of patients.859. and 903. Reduced sweating has also been documented. 904 Rarely it may masquerade as other alopecias such as trichotillomania798 and frontal fibrosing alopecia. 905 Migratory poliosis may be a forme fruste of alopecia areata. 906 Although eyebrow loss may occur in alopecia areata, diffuse eyebrow loss can occur in a familial setting in the absence of scalp hair loss. 907
Alopecia areata incognita is a variant of alopecia areata characterized by acute diffuse shedding of telogen hairs in the absence of typical patches. 908 Clinically it has the features of telogen effluvium. Scalp dermoscopy shows characteristic round or polycyclic yellow dots and numerous short regrowing hairs. 908 Fine depigmented hair may be present. 909
Although the pathogenesis of alopecia areata is not understood, the evidence for an immunological basis comes from five sources:845.910. and 911. the clinical association of other autoimmune diseases, the presence in some patients of circulating antibodies directed to a range of hair follicle antigens,912.913. and 914. altered cellular immune functions,915. and 916. the favorable effects of treatment with synthetic immunomodulators,917. and 918. and the histopathological finding of activated and autoreactive T cells and HLA-DR expression919. and 920. in the vicinity of the hair bulb.921. and 922. Antibodies against hair follicles are present in patients with alopecia totalis occurring in association with the autoimmune polyendocrine syndrome type I (OMIM 240300). 923 This syndrome is due to mutations in the autoimmune regulator (AIRE) gene on chromosome 21q22.3. Not only are antibodies present in this syndrome but also alopecia areata. 924 Alopecia areata has developed in a leukemic patient after allogeneic bone marrow transplantation from an affected sibling. 925 The initial stages of the disease involve T lymphocytes and dendritic cells that are CD1a and CD36 positive.926.927. and 928. Serum chemokines, such as MIG (monokine induced by interferon-γ) and RANTES, are increased in alopecia areata and are useful markers of disease activity. 929 The lymphocytes appear to be of oligoclonal origin. 930 One study suggests that CD8+ cells, even though they are less frequent than CD4+ cells in the infiltrate, play an important pathogenic role, with the CD4+ cells in their classic helper/supporter role.931.932.933.934.935. and 936. Both CD4+ and CD8+ lymphocytes express cutaneous lymphocyte-associated antigen (CLA). 937 The levels of IL-2R, IL-5, and IL-6 are significantly higher in cultured blood monocytes from patients with patchy alopecia areata than in controls. 938 Treatment with diphencyprone leads to an increase in CD8+ cells and a significant decrease in CD4+ cells. 939 Interleukin-4 production may be impaired. 940 Adhesion molecule receptors are involved in the initial trafficking of leukocytes into the dermis. 926 The effect of psychological factors, which play an important role in some patients with alopecia areata, may be mediated by neuropeptide substance P which is increased in nerve fibers in areas of hair loss. 941
The basic disturbance is the premature entry of anagen follicles into telogen, although some follicles survive for a time in a dystrophic anagen state. 942
The term ‘nanogen’ has been proposed for the morphologically distorted telogen follicle that is produced in alopecia areata. 943 Follicles may re-enter anagen, but growth appears to be halted in anagen stage III and IV. 944 Interestingly, follicles producing non-pigmented hair are less susceptible to premature telogen. 837 Cell deletion by apoptosis, probably cell mediated, is the mechanism by which premature catagen and telogen come about. Apoptosis may also play a role in the anagen arrest that occurs. 944 Graft experiments suggest that hair growth ability in situ is normal and the causation is mediated humorally. 945
Considering the poor results obtained in the treatment of severe alopecia areata, including the totalis and universalis forms, there is a remarkable paucity of trials attempting to address this situation. For patchy alopecia, treatment with topical and/or intralesional corticosteroids, diphencyprone, and topical minoxidil 5% are considered the most effective treatments.841.858.939. and 947. A publication in 2008 concluded that topical diphencyprone ‘is considered the most effective treatment of alopecia areata’. 948 For more extensive disease other treatments are usually necessary, but results are variable and often poor. They include topical dinitrochlorobenzene (DNCB), 949 squaric acid, 858 PUVA therapy,950. and 951. weekly oral or subcutaneous methotrexate, with or without low dose (oral) corticosteroids, 952 sulfasalazine, 953 and oral or pulse intravenous corticosteroids (but many relapse when it is discontinued).954. and 955. Efalizumab and extracorporeal photopheresis have been unsuccessful.956. and 957. Some success has been reported with hypnotherapy, but the trial was not controlled in any way. 958 Results in patients with the totalis and universalis forms are poor with less than 20% of patients obtaining complete hair regrowth. 952 Finally, regrowth of hair in a patient with alopecia areata universalis occurred after a bone marrow transplant given in the treatment of Hodgkin’s disease. 959
The appearances vary according to the duration of the process at the biopsy site (Fig. 15.19). At the expanding edge the majority of the follicles are in late catagen and telogen. A few anagen follicles are in the subcutis while small (miniaturized) mid-dermal ones may also be seen. The larger anagen follicles show a peribulbar infiltrate of lymphocytes (likened to a swarm of bees) and macrophages and sometimes a few eosinophils and plasma cells (Fig. 15.20). 942 They are found around terminal hairs in early stages and around miniaturized anagen hairs in repeated episodes. 960 Peribulbar inflammation tends to subside as affected follicles enter the telogen phase, but occasionally a few inflammatory cells can still be found around telogen follicles. 695 It should be stressed that an inflammatory infiltrate is not always found in alopecia areata, particularly in chronic disease. Eosinophils were present in the fibrous tracts and near hair bulbs in 38 of 71 cases in one study, 961 and in 11 of 51 cases in another. 962 Mast cells are common in the fibrous tracts but they can also be found in androgenetic alopecia. There is also exocytosis of inflammatory cells into the bulbar epithelium. 963 The majority of the lymphocytes are small and mature. 964 Some Langerhans cells are also present. The small anagen follicles show a disproportionate reduction in the size of the epithelial matrix relative to that of the dermal papilla. In another study of the early changes in terminal anagen hair follicles, peribulbar lymphocytes were seen associated with destruction of the upper bulb up to the keratogenous zone. 965 There were clefts between keratinocytes which had a ‘crumbled’ appearance. The hair matrix was initially intact but eventually the papilla was no longer embraced by the matrical epithelium. 965 By this stage the bulb showed advanced shortening with numerous apoptotic cells, indicative of catagen hairs. Kamino and colleagues have stated that although lymphocytes extend up to the bulge region of the follicle, they do not target stem cells as in lichen planopilaris. 966
(A) Alopecia areata. This is a late stage lesion with a complete loss of follicles. (B) A fibrous tract extends along the site of the previous follicle. A small, early anagen follicle is above. A few lymphocytes are also present. (H & E)
Alopecia areata. Lymphocytes surround the bulbar region, giving the characteristic ‘swarm of bees’ sign. (H & E)
In established cases and in alopecia totalis there are many telogen follicles and some small anagen follicles with mid-dermal bulbs. 942 There are a decreased number of terminal anagen hairs. The anagen/telogen ratio is variable. Although routine sections give the impression of marked follicle loss because of the absence of follicles in the subcutis, the use of transverse sections allows a better assessment of follicle density. 688 A quantitative study, using horizontal sections, found an average of 40 hairs in a 4 mm biopsy of normal scalp, but only 27 in alopecia areata. 967 The study also showed an increase in vellus follicles and also of telogen follicles in alopecia areata. 967 This has prognostic significance because it indicates that normal regrowth of hair is theoretically possible in these circumstances. 688 There is only a mild peribulbar inflammatory cell infiltrate around these small anagen follicles. Occasional apoptotic cells and mitoses can be seen. Empty infundibula are common. Pigment incontinence is seen around the site of the previously deeper hair bulbs. Atrophy of sebaceous glands is seen sometimes in long-standing cases. 968 Incidental follicular mucinosis has been reported. 969 Dermal mucin is a rare finding. It may signify underlying lupus erythematosus. 970
In regenerating areas, the number of melanocytes and the degree of pigmentation of the cells in the hair bulb are much less than in the normal pigmented follicle.942. and 944.
In all stages, a non-sclerotic fibrous tract extends along the site of the previous follicle into the subcutis. This stela represents a collapsed fibrous root sheath. This fibrous tract contains a few small vessels and small deposits of melanin. In cases of long standing there is widespread damage and fibrosis to the follicular sheath structures. There may be only a few lymphocytes and macrophages at the site of the previous hair bulb. There are no Arão–Perkins elastic bodies along this connective tissue tract, such as are seen in male pattern (androgenetic) alopecia. 971
Assessments have been made of scalp biopsies from patients with long-standing alopecia totalis and universalis who did not respond to sensitizing therapies. 968 From a pathological viewpoint, non-responder patients constitute a heterogeneous population with early regrowth, telogen, scarring, and early anagen arrest patterns present in different patients. 968
Kossard has presented a case with miniaturized follicles and a heavy (non-lichenoid) lymphocytic infiltrate at the level of the stem-cell rich region near the entry of the sebaceous duct. 972 He considered that it might be a variant of alopecia areata and used the term ‘diffuse alopecia with stem cell folliculitis’. 972 Stem cell apoptosis has also been seen in HIV-associated alopecia. 973
Immunofluorescence shows deposits of C3 and occasionally of IgG and IgM along the basement zone of the inferior segment of hair follicles. 974Careful ultrastructural studies are needed to assess the role of lymphocyte-mediated apoptosis in the pathogenesis of this disease.
Apoptosis has been seen not only in the outer root sheath of catagen follicles but also in matrix keratinocytes and anagen hair bulbs. Dark cell transformation is also present. Ultrastructural studies of exclamation mark hairs show asymmetrical cortical disintegration below the frayed tip. 976 Cells in the dermal papilla show signs of injury and there are abnormal amounts of pigment. 977
This group of alopecias is characterized by the presence of small vellus follicles in the dermis. In androgenetic alopecia (common baldness), which is the most important member of this group, an early biopsy may only show a progressive diminution in the size of follicles which are not truly vellus. In established lesions typical vellus follicles will be seen. Vellus follicles are also a feature of temporal triangular alopecia but this presumably represents the development of vellus follicles in the affected site ab initio rather than the progressive reversion of terminal hair follicles to vellus follicles.
Androgenetic alopecia (common baldness, androgenic alopecia) is a physiological event which may commence in males soon after puberty.978. and 979. It occurs less often in females and its onset is a decade or so later than in males. It has been said to affect at least 50% of men by the age of 50 years, 980 and 80% at the age of 70 years, 981 while it affects about 40% of women aged 70 years and over. 982 The hair loss is more obvious in men. Clinically there is progressive replacement of terminal hairs by fine, virtually unpigmented vellus hairs, with hair loss in distinct geographical areas of the scalp. 983 Hair diameter diversity is an important clinical sign that reflects the underlying follicular miniaturization characteristic of this condition. 984 Increased shedding of hairs is usually noted. 978 In females, there may be features of hyperandrogenism such as hirsutism and acne. 985 However, it has been reported in a female with hypopituitarism, indicating that it is not always androgen dependent. 986 Cigarette smoking may predispose to androgenetic alopecia, 987 although this was not confirmed in another study. 981
In males, the hair loss is patterned and involves the frontal, central, and temporal regions. Uncommonly, there is sparing of frontoparietal hairline in men. 988 Various categories of male baldness have been defined, based on which of the above areas are involved.978. and 989. Hair loss may have an important psychological effect, particularly in younger males.990. and 991.
In females, three distinct patterns of hair loss have been recognized.992.993.994. and 995. The most common type is a diffuse frontovertical thinning without temporal recession. 985 The second type is similar to that seen in the male (male pattern alopecia). It is often associated with virilism, although in one study it was found in a significant number of normal postmenopausal women. 996 The third pattern is diffuse thinning confined to the vertex and developing after the menopause. 992 A midline part will reveal a characteristic decrease in hair density from the vertex to the front of the scalp. 997 In endocrinologically normal females, the rate of progression of the alopecia is very slow. However, it should always be kept in mind that androgenetic alopecia, in both sexes, may be accompanied or unmasked by other forms of hair loss such as alopecia areata, telogen effluvium, or the hair loss associated with hypothyroidism and even with iron deficiency.821. and 998. The term ‘female pattern hair loss’ is preferred by some workers in this field for female patients, rather than the term androgenetic alopecia. 999
A new classification of pattern hair loss, applicable to both men and women, has been devised. 1000 It has considerable merit, but it will not be discussed in detail, because it is yet to gain acceptance. 1000
Androgenetic alopecia results from a progressive diminution in the size of terminal follicles with each successive cycle and their eventual conversion to vellus follicles.978. and 1001. This vellus conversion occurs under the influence of androgenetic stimulation or in individuals with genetic predisposition. 985 The actual mechanism of this miniaturization has never been clearly elucidated. Whiting has postulated an abrupt process with a reduction in cell numbers of the dermal papilla. 1002 Rebora has postulated three mechanisms: an androgen-induced acceleration of the mitotic rate of the matrix that leaves less and less time for differentiation; an increased telogen shedding; and the increased number and duration of the lag phase (kenogen), the true resting period of the follicle after telogen. 717 Other studies support the notion that the dermal papilla cells represent the androgen target within the hair follicle. 1003 The androgen receptor coactivator ARA70/ELE1 is reduced in androgenetic alopecia. 1004
The method of inheritance has not been clearly defined. It is probably polygenic. No relationship with the 5α-reductase gene or the human hairless gene has been found.1005.1006.1007. and 1008. The microsomal enzyme steroid 5α-reductase is responsible for the conversion of testosterone into the more potent androgen dihydrotestosterone. 1009 Androgenetic alopecia is common in adrenoleukodystrophy, an X-linked recessive condition. 1010 In contrast, it is uncommon in patients with Kennedy’s disease (OMIM 313200), a neurodegenerative disease due to a mutation in the androgen receptor (AR) gene on chromosome Xq11–q12. 1011 Racial influences also play a part. 985 The age-specific prevalence in certain Asian countries is lower than that seen among white people.987.999. and 1012.
Elevated urinary1013 and sometimes serum dehydroepiandrosterone levels have been noted in male pattern alopecia. 1014 Hair follicles from sites involved with baldness have shown altered levels in the activity of the enzyme responsible for the conversion of certain androgens to their more active metabolites. 1015 Hyperandrogenism has been detected in approximately 40% of females with the diffuse type of alopecia.992. and 1016. Sebum excretion is not increased in females. 1017 Polycystic ovaries are frequently the cause of this hyperandrogenetic state. 1016 Ovarian hyperthecosis may also cause androgenetic alopecia in postmenopausal women. 1018 Antiandrogen therapy (see below) will result in some improvement in up to 50% of patients, but this is usually confined to a decreased rate of hair loss. 1019 The insulin growth factor 1 (IGF-1) axis may be important in the etiology of patterned hair loss in males.1020. and 1021. Increased expression of IGF-1 messenger RNA levels in the dermal papilla of patients with androgenetic alopecia is associated with response to finasteride, 1003 a selective inhibitor of type 2 5α-reductase, which appears to be capable of reversing the miniaturization of follicles in androgenetic alopecia of younger males, but not in postmenopausal women.1022. and 1023.
The treatment of this condition differs in males and in females with female pattern hair loss. This topic was reviewed in 2008. 1024 In males, both finasteride 1 mg and minoxidil topical solution (2% or 5%) can be used. Both retard further thinning and increase scalp coverage but neither drug restores all lost hair or is able to reverse total baldness. 999 Both require long-term use. Treatment should be used for 12 months before making a decision about efficacy. There are no well-controlled studies on the effects of using a combination of these two therapies, although an additive effect was observed in an animal model. 999 Finasteride, which inhibits type 2 5α-reductase leading to decreased levels of scalp and serum dihydrotestosterone, appears to be more effective in males under the age of 26 with initial high levels of 5α-dihydrotes-tosterone. 1025 Improvement is much slower or absent over this age. 1025 Finasteride produces improvement in hair weight, indicating that factors other than the hair count are important in producing the beneficial effect of improved hair coverage.1026. and 1027. Improvement is often less in the occipital area. 1028 A randomized trial in 2006 of dutasteride, which inhibits both type 1 and type 2 5α-reductase, showed it to be superior to both the placebo and finasteride at 12 and 24 weeks. 1029Minoxidil, a potassium channel opener producing vasodilation, increases the duration of anagen and enlarges miniaturized follicles. 999 In another trial, 5% minoxidil foam was found to be superior to placebo in the treatment of androgenetic alopecia in males. 1030
In female pattern hair loss, finasteride has less efficacy than in males. 1031 Earlier trials, which did not stratify cases according to whether hyperandrogenism was present must be viewed with this factor in mind, as finasteride can be effective in women with hyperandrogenism,1032. and 1033. but less than 40% of women with female pattern hair loss have hyperandrogenism. 999 In an uncontrolled trial, 2.5 mg (instead of the usual 1 mg) of finasteride, when combined with an oral contraceptive pill, produced some improvement in 62% of patients, but no mention was made of their androgen status. 1034 Finasteride has not been effective in postmenopausal women. 999 Spironolactone and cyproterone acetate may be useful in a small subgroup of women, although one trial of these antiandrogens concluded that 88% of women receiving these therapies could expect no improvement. 1035
For all women, not related to androgen status, both 2% and 5% topical minoxidil was found to be superior to placebo in the treatment of female pattern hair loss. 1036 There were fewer side effects with the 2% solution. 1036
The earliest change in androgenetic alopecia is focal basophilic degeneration of the connective tissue sheath of the lower one-third of otherwise normal anagen follicles. 978 The terminal follicles become progressively smaller and a proportion regress to the vellus state (Fig. 15.21). This progressive miniaturization of hair follicles and their shafts is best assessed on transverse sections.685.963. and 1040. The random intermingling of miniaturized and terminal follicles has been called anisotrichosis, analogous to anisocytosis of the peripheral blood film which is characterized by red cells of variable size. 1041 Even the matrix and dermal papillae are reduced in size. 1042 There is a decreased proliferation of keratinocytes as evidenced by the significant decrease in Ki-67 expression. 1043 Only in very advanced stages do the vellus follicles disappear, leaving thin hyaline strands in the dermis. 686 Some quiescent terminal follicles are present until a late stage and it is these which produce hairs under the influence of minoxidil. 1044 Progressive fibroplasia of the perifollicular sheath appears to be a common process; this may result in the miniaturization of the follicle, rather than being a consequence of it.1045. and 1046. Computerized morphometry may be used to quantify follicular size and hair diameter. 1047
Androgenetic alopecia. A small vellus follicle is dwarfed by the adjacent sebaceous gland. (H & E)
There is also an increase in the number of telogen and catagen hairs relative to the number of anagen hairs.978. and 1043. In one study, telogen hairs constituted 16% of the total, compared to 6.5% in normal subjects. 1048 This results from a shortening of the anagen cycle. This altered telogen/anagen ratio cannot be appreciated in conventional sections because only a small number of follicles are present in the plane of section. However, if transverse sections are taken of the biopsy then a greater number of follicles are available for study. 688 The decreased hair diameter can also be quantified in these sections.
In the connective tissue streamers that lie beneath the vellus follicles, small elastin bodies can be seen. They are known as Arão–Perkins bodies and they indicate the sites of the papillae of each preceding generation of follicles. 683 They can be stained with the acid orcein method, but not the Verhoeff elastic stain. 683
It is usually suggested that the sebaceous glands are increased in size, number, and lobulation. 1039 However, planimetric studies have shown that the total number of sebaceous glands is significantly decreased. 978 The arrectores eventually diminish in size, but this lags behind the follicles. Accordingly, relatively large arrectores can usually be seen attached to the connective tissue streamers (follicular stelae) below the small vellus follicles.
Other changes that may be present include mild vascular dilatation and a mild perivascular round cell infiltrate which often includes mast cells. 1039 This has been called ‘microinflammation’. 1046 Infrabulbar and peri-isthmic inflammation are rare, but when present, this so-called inflammatory variant, with histological features that overlap alopecia areata and Kossard’s chronic stem cell folliculitis, may be an indication of reduced response to treatment.972. and 988. Multinucleate giant cells are present in up to one-third of biopsies. 1049 Small nerve networks, resembling encapsulated end organs, may be seen. Solar elastosis and some thinning of the dermis may also be present in cases of long standing. Differences in staining for bcl-2 have been observed in clinically affected and unaffected scalp. 1050
Female pattern alopecia is usually regarded as having similar, if not identical, morphological features to those seen in males. 1038 It has been suggested that the reduction in follicular size might result from a preferential loss of large-diameter terminal hairs rather than a true miniaturization of follicles. 1051 One study showed frequent catagen follicles in the female type with a paucity of telogen follicles. 1052 Numerous vellus follicles were also present.
Distinguishing chronic telogen effluvium from androgenetic alopecia may be difficult, especially when associated in the same patient. 1053 A distinction can be made based on the number of hairs shed after washing the hair in a standardized way, and the length of the hairs shed. Small telogen vellus hairs were associated with androgenetic alopecia while greater shedding (>100 hairs) and length of hair over 3 cm correlated with telogen effluvium. 1053
Temporal triangular alopecia consists of a triangular patch of alopecia with its base extending to the frontotemporal hairline.1054.1055.1056. and 1057. Most cases develop during the first few years of life; the original designation ‘congenital triangular alopecia’ is a misnomer.1058. and 1059. It is usually unilateral. Fine vellus hairs are often present in the area. 1055 It has been misdiagnosed clinically as refractory tinea capitis. 1060
It has been reported in association with colonic polyposis, eye defects, mental retardation and phakomatosis pigmentovascularis, and also with congenital heart and other anomalies.1061.1062. and 1063. It has also occurred in combination with androgenetic alopecia. 1064 The pathogenesis remains unknown. 1065
There is replacement of the normal abundant terminal follicles of the scalp by vellus follicles. Nanogen-like hairs are often present. Sebaceous glands and the dermis appear normal.
Anagen defluvium (anagen effluvium) is the loss of anagen hairs, either because they are defective and break or, rarely, because they are easily detached from the hair follicles. 686 The hair loss may be patterned or diffuse and it appears 1 month or less after the causative event, much faster than the hair loss in telogen effluvium. 807
Defective hairs that break easily occur in several hair shaft abnormalities such as pili torti, trichorrhexis nodosa, and monilethrix. 686 They also develop following antimitotic agents, various drugs, thallium, arsenic, vitamin A intoxication, and X-ray therapy. 686 Although anagen defluvium (effluvium) has been regarded as the method of hair loss, a recent study implicated telogen effluvium as the cause. 823 Other causes include trauma, thyroid disease, hypopituitarism, deficiency states, infections of the follicle or hair shaft, and alopecia areata.686. and 807.
Easy detachment of anagen hairs is a rare cause of anagen defluvium, occurring in follicular mucinosis, lymphomatous infiltration of the hair follicles, and the rare loose anagen syndrome (see below).
In most instances, the diagnosis is made on clinical grounds and scalp biopsies are rarely performed. Two disorders, the loose anagen syndrome and drug alopecia, will be considered in further detail. It should be noted that various mechanisms may be involved in drug alopecias.
Loose anagen (hair) syndrome (OMIM 600628) is a recently delineated entity of childhood in which anagen hairs are easily pulled from the scalp of affected individuals, who present with diffuse hair loss.1066.1067.1068.1069. and 1070. It results from a disorder of adhesion of anagen hairs between the hair cuticle and inner root sheath cuticle leading to impaired anchorage of hairs to their follicle.1071. and 1072. It may sometimes be mimicked by alopecia areata. 1073 Some improvement in the alopecia occurs with increasing age. Children usually present with slow-growing hair that seldom requires cutting. 1074 Short anagen syndrome also presents in this way. 786 Adult onset has been recorded.
The hair-pluck trichogram shows a high proportion of loose anagen hairs, but the hair-pull test varies over time. 1071 There are even periods when no hairs can be obtained. 1071
Trichotillomania, probably related to child abuse, has been superimposed on this syndrome, increasing the hair loss. 1075
The syndrome has been associated with ectodermal dysplasia, with woolly hair, 1076 and with a Noonan-like syndrome (OMIM 607721). 1077 A mutation in the hair keratin gene K6HF (now KRT86) has been found in a few cases. 1074
Abnormal keratinization of Huxley’s and Henle’s layers of the inner root sheath has been found in some samples. 1067 The keratogenous zone of the follicle appears shorter than normal. 1078 Marked cleft formation between hair shafts and regressively altered inner root sheaths were noted in another study. 1066 The easily extracted hairs are misshapen anagen hairs without external root sheaths. 1067
Alopecia induced by drugs usually presents as diffuse, non-scarring hair loss that is reversible upon withdrawal of the drug.1079.1080. and 1081. It is a common complication of the various antimitotic agents used in the chemotherapy of cancer, 1082 but it may also occur as a rare complication of other therapeutic drugs. 1083 It is now being described with the epidermal growth factor receptor (EGFR) inhibitors.1084. and 1085. They may affect both growth and hair texture. A nationwide outbreak of alopecia has been reported in the United States, associated with the use of a commercial hair-straightening product. 1086 The low pH of the product may have been responsible. Hair care products are widely used, and although sometimes implicated as a cause of hair loss, this complication is exceedingly rare, if it happens at all. 1087
Drugs may interfere with hair growth in a number of different ways. For example, thallium, 1088 excess vitamin A, retinoids, and certain cholesterol-lowering drugs interfere with the keratinization of the hair follicle.1079.1089. and 1090. The antimitotic drugs interfere with hair growth in the anagen phase by interrupting the normal replication of the hair matrix cells. 1080 Other drugs induce telogen effluvium and the follicles remain in the resting phase.
Besides those already listed, drugs that may induce alopecia include anticoagulants, antithyroid drugs, chemicals used in straightening hair,1086. and 1091. anticonvulsants, hormone-related substances such as clomiphene, heavy metals such as lead, bismuth, arsenic, gold, mercury and lithium, antibacterial agents such as gentamicin, nitrofurantoin and ethambutol, and non-steroidal anti-inflammatory or antihyperuricemic agents such as naproxen, ibuprofen, allopurinol, probenecid and indomethacin.1079.1080. and 1092. The anticonvulsant valproate may cause depigmentation of hair, rather than alopecia. 1093 Drugs that have been incriminated rarely include amphetamines, vasopressin, 1094 beta-blocking agents, cimetidine, levodopa, methysergide, penicillamine, bromocriptine, borates, 1095 quinacrine (mepacrine), selenium, and tricyclic antidepressants. 1080 Localized alopecia has been reported at the injection site of interferon alfa-2b. 1096 A detailed listing is contained in the review article by Pillans and Woods. 1081
Those drugs producing telogen effluvium will induce catagen changes in many of the follicles. By the time a biopsy is taken, the follicles have usually entered the telogen phase. The antimitotic agents also induce premature catagen transformation. At a later stage the follicles enter anagen but their growth is then arrested at various stages of development.
The scarring (cicatricial) alopecias are an etiologically diverse group that share in common the destruction of hair follicles associated with atrophy and/or scarring of the affected area, usually leading to permanent hair loss. 1097 They may result from intrinsic inflammation of the hair follicle (folliculitis) or destruction of follicles by an inflammatory or neoplastic process external to them. 1098
Recently, attention has focused on the role of the sebaceous gland in scarring alopecia. Stenn and colleagues have drawn attention to the fact that the sebaceous gland is lost in the early phases of scarring alopecia. 1099 The mutant asebia mouse has hypoplastic sebaceous glands. It soon develops a scarring alopecia, support for the theory that primary sebaceous gland pathology may be involved in some scarring alopecias. 1099
The scarring alopecias may be classified on an etiological basis, as follows: 1098
• Developmental and related disorders
epidermal nevus
aplasia cutis
incontinentia pigmenti
keratosis pilaris atrophicans
porokeratosis of Mibelli
ichthyosis vulgaris
Darier’s disease
epidermolysis bullosa (recessive dystrophic)
polyostotic fibrous dysplasia
• Physical injuries
mechanical trauma, including pressure/traction
thermal, electric and petrol burns
radiodermatitis
therapeutic embolization1100
• Specific infections
certain fungal infections (including kerion and favus)
herpes zoster and varicella
pyogenic folliculitides
lupus vulgaris
syphilis (late stages)
leishmaniasis
• Specific dermatoses
lichen planus and variants
lupus erythematosus
scleroderma and morphea
necrobiosis lipoidica
necrobiotic xanthogranuloma
lichen sclerosus et atrophicus
sarcoidosis1101
amyloidosis
cicatricial pemphigoid
follicular mucinosis
folliculitis decalvans
dissecting cellulitis of the scalp
• Neoplasms (alopecia neoplastica)
basal and squamous cell carcinomas
angiosarcoma
lymphoma
secondary tumors
• Idiopathic
idiopathic scarring alopecia (pseudopelade)
traction alopecia with scarring
postmenopausal frontal fibrosing alopecia
fibrosing alopecia in a pattern distribution
tufted-hair folliculitis.
With the exception of the idiopathic scarring alopecias, the above conditions have all been discussed in other sections of this volume.
Attention has been given in recent years to the regrouping of some of the scarring alopecias into an orderly classification. Sperling, Solomon, and Whiting have looked at the central centrifugal scarring alopecias, 1102 while Sullivan and Kossard have grouped together the pustular scarring alopecias. 1103 These concepts are considered below. Readers are referred to the etiological classification above. It still provides a convenient checklist of the various scarring alopecias.
Two recent publications have attempted to bring some order to the confusing area of scarring alopecias. Although not followed here, they are worthy of some mention. Sullivan and Kossard have given a detailed classification of the scarring alopecias. 1103 Their categorization of the pustular scarring alopecias is worth repeating (Table 15.2).
The second publication, by Sperling, Solomon, and Whiting, discussed the concept of central centrifugal scarring alopecia. 1102 This term is a clinical one that includes patients with (1) hair loss centered on the crown or vertex, (2) chronic and progressive disease with eventual ‘burnout’, (3) symmetrical expansion, and (4) clinical and histological evidence of peripheral inflammation.1102. and 1104. Their concept encompasses:
• follicular degeneration syndrome
• pseudopelade (idiopathic scarring alopecia)
• folliculitis decalvans
• tufted folliculitis.
However, while fibrosing alopecia in a pattern distribution would seem to fit this definition, frontal fibrosing alopecia does not. Yet they would logically seem to fit together in any clinicopathological correlation. Furthermore, the above classification seems to include disorders with diverse etiologies, at least in our current state of ‘knowledge’.1105. and 1106. Another criticism of this concept has been provided by Ackerman and colleagues, who point out that there is no such entity as the follicular degeneration syndrome, which is in reality a traction alopecia. 805 Interestingly, traction alopecia, fibrosing alopecia in a pattern distribution, and postmenopausal frontal fibrosing alopecia all share a lichenoid perifolliculitis in the early stages. It may be that various stimuli are capable of altering the antigenicity of follicular cells, leading to a lichenoid (cell-mediated) reaction.
A histopathological classification of cicatricial alopecias is given below. It is based on the workshop sponsored by the North American Hair Research Society Workshop held in 2001, 1107 and other subsequent publications.685.1108.1109. and 1110. Scarring alopecia associated with mastocytosis is not accommodated in this classification. 1111
Lymphocytic cicatricial alopecias
• Cutaneous lupus erythematosus
• Lichen planopilaris/frontal fibrosing alopecia/Graham Little–Piccardi–Lassueur syndrome
• Central centrifugal alopecia (including ‘hot comb’ alopecia, traction alopecia with scarring) – concept not accepted by all1110
• Alopecia mucinosa
• Keratosis follicularis spinulosa decalvans
• Classic pseudopelade of Brocq (including idiopathic scarring alopecia)
Neutrophilic cicatricial alopecias
• Folliculitis decalvans
• Tufted folliculitis
• Dissecting folliculitis
Mixed lymphocytic/neutrophilic cicatricial alopecias
• Folliculitis (acne) keloidalis
• Acne necrotica
• Erosive pustular dermatosis
Non-specific (end-stage) cicatricial alopecia
• Many different inflammatory alopecias can have non-specific end-stage features.
In a recent publication, by several experienced dermatopathologists, a clinicopathological correlation of six clinically distinct primary cicatricial alopecias was attempted using this method: lichen planopilaris, frontal fibrosing alopecia, pseudopelade (Brocq), centrifugal alopecia, folliculitis decalvans, and tufted folliculitis. The lymphocytic and neutrophilic groups (folliculitis decalvans, tufted folliculitis) could be readily distinguished according to the earlier North American Hair Research Society classification, 1107 but within the two groups, the clinically distinct entities could not be distinguished on their histopathology. 1108 Premature desquamation of the inner root sheath has been regarded as a defining histological feature of central cicatricial alopecia but it can also be seen in many other types of alopecia.350. and 1112.
In another study of 112 patients from Vancouver, Canada the ratio of lymphocytic to neutrophilic cicatricial alopecias was 4 : 1. 1113 Whereas lymphocytic alopecias had a tendency to affect middle-aged women, the neutrophilic ones had a predilection for middle-aged men. The pathogenesis of the scarring alopecias has received recent attention. It has been suggested that destruction of follicular stem cells is a possible mechanism in lichen planopilaris, the prototype scarring alopecia (see p. 43). A subsequent study has failed to confirm a T-cell-mediated destruction of follicular bulge stem cells in primary scarring alopecia. 1114
Treatment options for the lymphocytic variant include corticosteroids, antimalarials, and isotretinoin. Antibiotics, corticosteroids, and isotretinoin can be used for the neutrophilic ones.1110. and 1113. In 2008, Harries et al published an excellent, evidence-based review on the treatment options for the various primary cicatricial alopecias. 1115
Idiopathic scarring alopecia (fibrosing alopecia,683. and 971. alopecia cicatrisata, pseudopelade) is a rare, asymptomatic form of scarring alopecia in which there is patchy hair loss not accompanied by any clinical evidence of folliculitis, lichen planus, lupus erythematosus, or any of the specific diseases listed above. 1116 The term ‘idiopathic scarring alopecia’ is preferred to the more commonly employed name pseudopelade, which has been used in the past in a variety of contexts:1117.1118. and 1119. it has been applied to end-stage scarring alopecias following known dermatoses such as lichen planus and lupus erythematosus.1120. and 1121. It is conceded that the term ‘pseudopelade’ has some use in a clinical setting to refer to a scarring alopecia, the cause of which is not yet known, but it should not be used to refer to a clinicopathological entity. 1122 The term ‘idiopathic scarring alopecia’ is used infrequently these days.
Idiopathic scarring alopecia tends to affect females over the age of 40 years. It has an insidious onset and a chronic, usually slowly progressive course. It results in slightly depressed patches of irreversible hair loss which may occur singly or in groups that have been described as resembling ‘footprints in the snow’. 686 The small patches may coalesce to form larger patches of scarring alopecia. Both the scalp and beard area were involved in one patient. 1123 As the designation ‘idiopathic’ implies, the etiology is unknown.
Fibrogenic cytokines (IL-4, IL-6, fibroblast growth factor (bFGF), and TGF-β) were demonstrated in all scarring alopecias tested in one series. 1124
In established lesions there is loss of hair follicles and sebaceous glands and these are replaced by bands of fibrous tissue containing elastic fibers (Fig. 15.22). These bands extend above the level of the attachment of the arrectores pilorum, in contrast to normal telogen where the fibrous tissue replaces only the deeper part of the hair follicle. In transverse sections, a prominent perifollicular lamellar fibroplasia is usually seen.689. and 1125.
Idiopathic scarring alopecia. A band of fibrous tissue is present at the site of a destroyed hair follicle. (H & E)
In early lesions, a moderately heavy infiltrate of lymphocytes surrounds the upper two-thirds of the follicle. It has been suggested that these may extend into the follicle, producing its massive apoptotic involution. 1126 The epidermis is not involved by the inflammatory infiltrate. In late lesions the epidermis may show some atrophic changes with loss of the rete ridge pattern.
The orcein and Verhoeff–van Gieson elastic stains may provide useful information in the scarring alopecias.971. and 1127. Whereas the fibrous tracts associated with the scarring alopecia of lichen planopilaris and lupus erythematosus are usually devoid of elastic fibers (this loss is more extensive in lupus erythematosus than in lichen planopilaris), there are elastic fibers in the fibrous tracts of idiopathic scarring alopecia and traction alopecia with scarring. 1127 In a proportion of cases elastic fibers develop around the lower cyclic portion of the hair follicle. 971
Direct immunofluorescence may also assist in the diagnosis of the scarring alopecias. 1128 In idiopathic scarring alopecia, immunofluorescence is negative, in contrast to lupus erythematosus in which a band of immunoglobulins and complement may be found along the basement membrane zone and surrounding hair follicles. 1128 In lichen planus, colloid bodies containing IgM and often C3 are present beneath the epidermis and around hair follicles. 1128 In ‘burnt-out’ lesions, direct immunofluorescence may be negative.
The term ‘traction alopecia with scarring’ is used in preference to ‘hot comb’ alopecia, central progressive alopecia in black females, and the follicular degeneration syndrome, for a form of scarring alopecia involving predominantly the crown of the scalp.1129. and 1130. Hairs at the periphery of the scalp are spared. It primarily affects black women. 1131 Traction alopecia was present in 22.6% of African adults (n = 874) examined in Cape Town; its prevalence was higher in women than men. 1132 It also occurs in African schoolchildren. 1133 Relaxers, chemicals used to straighten African hair, can produce a similar clinicopathological picture. 1134 Traction alopecia can be reduced/prevented by avoiding hairstyles with traction especially to chemically processed hair. 1135
While minor degrees of traction can produce hair loss without significant scarring, as in trichotillomania (see p. 421), prolonged and recurrent severe traction can result in scarring. Recently, Ackerman and colleagues have presented a detailed study of this entity, pointing out that there is no follicular degeneration in these cases, and that the use of this term is no longer justified. 805
Pressure (postoperative) alopecia is a related disorder seen rarely in patients who have undergone a major surgical procedure.695. and 1136. A few weeks later there is nearly total hair loss from the pressured area with sharp demarcation. The occipital area is commonly involved. Scarring also results in some of these cases.
As defined by Ackerman and colleagues, biopsies at an early stage show a lichenoid perifolliculitis in which infundibula are enveloped by lymphocytes with progressive perifollicular fibroplasia. 805 In fully developed lesions the infiltrate is sparse and the lower part of the infundibulum and isthmus are thinned, consequent to the fibroplasia. A granulomatous reaction to extravasated cornified material is present. This is followed by a loss of follicles and increased fibrosis with extension into the subcutis.
In the early stages of pressure alopecia there is often vascular thrombosis and inflammation. Nearly all the follicles are in catagen/telogen. Trichomalacia and pigment casts may also be found. 695 Infundibular dilatation of hair follicles may also be a feature in cases resulting from pressure. 1136
The Verhoeff–van Gieson elastic stain shows a hyalinized dermis with markedly thickened elastic fibers. The elastin sheath is preserved at the periphery of the broad fibrous tracts. 1127
The term ‘postmenopausal frontal fibrosing alopecia’ has been used for a progressive frontal scarring alopecia associated with perifollicular erythema.1137. and 1138. The eyebrows and axillary hair are lost in some cases, 1139 leading to the suggestion that it is related to the Graham Little–Piccardi–Lassueur syndrome. 1140 Kossard and colleagues have reported 16 cases, suggesting that it is more common than the paucity of reports would suggest. 1141 The histological features are generally thought to be indistinguishable from those seen in lichen planopilaris, but Tosti and colleagues have stated that unlike lichen planopilaris the lymphocytic infiltrate and fibrosis affect selectively the intermediate and the vellus-like follicles. 1142 Others have reported more apoptosis in frontal alopecia than in lichen planopilaris and less follicular inflammation. 1143 The absence of lesions of lichen planus elsewhere in most cases led to the suggestion that these cases might represent a unique follicular destruction syndrome mediated by lymphocytes and triggered by postmenopausal events. 1137 However, it has now been reported in a premenopausal woman with cutaneous lichen planus. 1144 It is best regarded as a variant of lichen planopilaris with selective involvement of certain androgen-dependent areas (see p. 43).1141. and 1142. It has followed hair transplantation for androgenetic alopecia. 1145 Dermoscopy can be used to distinguish the condition from alopecia areata. 1146 Loss of orifices is seen in all cases, but there are no yellow dots characteristic of alopecia areata. 1146
Fibrosing alopecia in a pattern distribution appears to be another variant of lichen planopilaris in which the immune reaction is directed against miniaturized follicles of androgenetic alopecia. 1147 That is, these persons develop inflammatory scarring alopecia affecting only the balding central scalp. 1102 The lichenoid infiltrate targets the upper follicle. Late lesions resemble end-stage lichen planopilaris. 1147
Folliculitis decalvans is sometimes considered to be a primary scarring alopecia. However, because inflammation of the follicle is a major feature, it has been considered with the folliculitides on page 406. Hair straightening and other cosmetic practices are a common cause of this condition in African-American women. 1148 Sperling believes that folliculitis decalvans in most cases represents a highly inflammatory form of central centrifugal cicatricial alopecia. 350
Tufted-hair folliculitis is characterized by areas of scarring alopecia with tufts of 10–20 hairs emerging from single follicular openings.1149.1150. and 1151. There is a predilection for the parietal and occipital areas. 1152 It is most likely a consequence of bacterial folliculitis involving the upper and mid follicle with rupture and scarring. It may complicate folliculitis decalvans,351. and 352. folliculitis keloidalis nuchae (acne keloidalis), and pemphigus vulgaris.1153.1154. and 1155. It has followed the use of cyclosporine. 1156
Antibiotics, both topical and systemic, are commonly used treatments, but complete cure is rare. 1152 A combined therapy of oral rifampicin and oral clindamycin for 10 weeks has been used. 352 It was effective in about one-half of the cases. 352
There is one rare form of alopecia that does not fit neatly into any of the other categories. It is called lipedematous alopecia.
Lipedematous alopecia, an acquired condition of unknown etiology, is characterized by a thick, boggy scalp with varying degrees of hair loss, occurring predominantly in adult black females.1158. and 1159. It is associated with a non-scarring but permanent alopecia. 1160 Irritation and pruritus are often present. 1161 It has been reported in association with discoid lupus erythematosus. 1162 There is doubling of the scalp thickness due to expansion of the subcutaneous fat layer. 1163 The term ‘lipedematous scalp’ has been used for cases without hair loss. 1164 The diagnosis can be confirmed by ultrasound.
Surgical debulking has been described as a method of management. 1165
There may be mild hyperkeratosis, acanthosis, and keratinous follicular plugging. Hair follicles are usually reduced in number. The most noticeable feature is a thickening of the subcutis, which appears to encroach upon the dermis (Fig. 15.23). 1163 The subcutis is edematous with disruption of fat architecture and cellular integrity. No inflammation or lipomembranous change has been described. Increased mucin was described in one case, 1164 but specifically excluded in others.1158. and 1166. The author has seen cases in which fat overgrowth without significant lymphedema produced a clinically similar condition. Lymphangiectasia has been present in two cases with hair loss. 1166 The significance of this change is uncertain.
Lipedematous alopecia. The subcutaneous fat encroaches on the dermis and extends to the level of the sebaceous gland. (H & E)
The colocalization of lipedematous scalp and nevus lipomatosus superficialis has been reported. 1167
In this section, the following miscellaneous topics will be covered:
• pilosebaceous disorders
• apocrine disorders
• eccrine disorders
• vestibular gland disorders.
A brief account of the embryology and anatomy of the sebaceous, apocrine, and eccrine glands will also be given.
The normal hair follicle has already been discussed earlier in this chapter. Its embryology and structure are considered on page 398 and the normal hair cycle on page 418.
The structure of the sebaceous gland will be considered here, followed by a discussion of various ‘miscellaneous’ disorders of the pilosebaceous unit, not previously considered.
The sebaceous gland develops as a bud from the primordial hair follicle in the 13th to 15th week of fetal life. It is a multilobular gland connected by a short duct to the hair follicle at the junction of the infundibulum and isthmus. The gland is comprised of a peripheral zone of basal cells which accumulate lipid in the cytoplasm as they move towards the center of the gland. The sebocytes eventually disintegrate at the level of the duct, releasing the mature sebaceous product, known as sebum, which acts as an emollient, bacteriostat, insulator, and pheromone. Sebaceous gland secretion is aided by contraction of the arrector pili muscle. 1168 Both structures form a follicular unit with the attached follicle. 1169
Sebaceous glands are distributed throughout the body except for the palms and soles. They are largest and most numerous in the skin of the face and the upper part of the trunk (the so-called ‘seborrheic areas’). The meibomian glands in the tarsus and the glands of Zeis at the lid margin are modified sebaceous glands.
The sebaceous glands increase in size at puberty. They atrophy in old age, particularly in females, although the number of glands remains the same. No major changes appear until the eighth decade of life in males. 1170 Overexpression of the aging-associated gene Smad7 correlates with sebaceous gland hyperplasia. 1170
There are several diseases of the pilosebaceous unit which do not fit readily into any of the categories discussed above. They include hypertrichosis, keratosis pilaris, keratosis pilaris atrophicans, follicular spicules, lichen spinulosus, rosacea, pyoderma faciale, and neutrophilic sebaceous adenitis. Rosacea is traditionally included with the pilosebaceous disorders although there is increasing evidence that it is not a primary disease of the appendages.
Congenital hypertrichosis lanuginosa is an exceedingly rare familial disorder, often inherited as an autosomal dominant trait, in which there is excessive growth of lanugo hair. 1174 Dental and eye abnormalities may also be present. 1175 Sporadic cases also occur. 1176
Acquired hypertrichosis lanuginosa is usually generalized, except for the palms and soles. An important cause is an underlying cancer, usually of epithelial type, 1179 although rarely a lymphoma is present. 1180 Hair growth may antedate the appearance of the tumor by months to several years.1181. and 1182. There may be rapid resolution after treatment of the malignancy. 1183 The pathogenesis is unknown. Vellus hairs, intermediate forms, and terminal hairs may also be increased in paraneoplastic cases, 1176 as well as in cases of porphyria, malnutrition and brain injury and, usually reversibly, in patients taking streptomycin, phenytoin (diphenylhydantoin), corticosteroids, penicillamine, psoralens, benoxaprofen, the vasodilators diazoxide and minoxidil, 1184 and cyclosporin A (cyclosporine).1171.1185. and 1186. Minoxidil-induced hypertrichosis may be limited to the face. 1187
Localized areas of hypertrichosis can be seen in congenital pigmented nevi, Becker’s nevus, overlying a neurofibroma, scrotal hair, 1188 hairy pinnae, hairy elbows (OMIM 139600),1178. and 1189. anterior and posterior cervical hypertrichosis (OMIM 239840),1178.1190. and 1191. nevoid hypertrichosis,1192. and 1193. spinal dysraphism (‘faun-tail’),1194. and 1195. ectopic cilia, 1196 and in depigmented hypertrichosis following Blaschko’s lines. 1197 Nevoid hypertrichosis is a congenital circumscribed patch of terminal hair without other abnormalities. It is usually solitary. 1173 It may be linear. 1198 Nevoid hypertrichosis has been successfully treated with the alexandrite laser. 1199
Moderate hypertrichosis of the lower extremities has been reported in a patient with mitochondrial encephalomyopathy with lactic acidosis and stroke-like episodes (MELAS syndrome). 1200 Other congenital syndromes associated with hypertrichosis1201 are listed in the review of this subject by Wendelin et al in 2003. 1173 A new entity reported since this review is the H syndrome (OMIM 612391), a genodermatosis characterized by indurated, hyperpigmented, and hypertrichotic skin with numerous systemic manifestations including short stature, cardiac anomalies, hypogonadism, and hepatosplenomegaly. 1202
Hypertrichosis may develop at sites of persistent friction and irritation in association with plaster casts and at sites of inflammation, including insect bites. 1203 Trauma may explain the paradoxical hypertrichosis that followed laser epilation. 1204 It has also developed at the site of measles immunization, 1205 and in association with a verruca vulgaris. 1206 It developed on the glans penis in an adult male, but no etiology was apparent. 1207 Facial hypertrichosis has been induced by efalizumab1208 and by cetuximab. 1209 Hypertrichosis of the eyelashes can be caused by drugs that lower intraocular pressure such as latanoprost and bimatoprost. 1210
There is extensive clinical evidence for the effectiveness of laser and light-based treatments in the removal of unwanted hair. 1211 Their mechanism of action is unknown. A study of follicular stem cells following laser treatment showed thermally altered hair shafts but intact stem cells, suggesting that functional alteration, rather than their destruction, may underlie the clinical efficacy of this treatment. Alternatively, completely different mechanisms may be involved. 1211
Little has been written on the histopathology of hypertrichosis. 1185 In the acquired form, the follicles have been reported to be small and deviated from their normal vertical position. They extend obliquely or even parallel to the epidermis and contain thin unmedullated hairs. The follicles are surrounded by small lipidized mantles representing sebaceous ducts showing early glandular differentiation. 1212
Keratosis pilaris (OMIM 604093) is a disorder of keratinization involving the infundibulum of the hair follicle. It is a common condition, being found in up to 5% of adult males and in 30% of females, particularly those showing hyperandrogenism and obesity. 1213 These figures obviously include cases of keratosis pilaris rubra (see below) that has not always been distinguished from keratosis pilaris itself. It is also increased in patients with insulin-dependent diabetes mellitus. 1214 The lesions, which vary from subtle follicular excrescences to more prominent follicular spikes, are found most often on the posterior aspect of the upper part of the arms and on the lateral aspect of the thighs and buttocks. 1215 Unilateral involvement has been reported. 1216 Onset is usually in childhood with remission in adulthood in some patients. 1217 Follicular keratotic plugs resembling keratosis pilaris may be found in keratosis pilaris rubra, keratosis pilaris atrophicans (see below), lichen spinulosus (see p. 434), pityriasis rubra pilaris, ichthyosis, psoriasis, some eczemas, lithium therapy, 1218 and uremia.1213.1219. and 1220. Keratosis pilaris itself has also been reported in the ectodermal dysplasias,1216.1221. and 1222. and in association with woolly hair. Large follicular keratotic plugs are seen in the amputation stumps of some patients with lower limb amputations and ill-fitting prostheses;1223. and 1224. they have also been seen as an idiopathic phenomenon. 1225 Follicular keratosis of the chin also appears to be due to prolonged pressure and friction. 1226
Keratosis pilaris rubra is characterized by substantial erythema, widespread involvement, and persistence after puberty. 1217 There is no atrophy or hyperpigmentation as seen in the atrophic variants. 1217 Erythema is sometimes present in keratosis pilaris, but it is usually mild and limited to the perifollicular skin.
It is thought that androgenic stimulation of the pilosebaceous follicle may result in the hyperkeratinization of the infundibulum. 1213 Flushing by autonomic dysregulation may have a role in the rubra variant. 1217
Numerous treatments have been used, reflecting the lack of a consistent response to any therapy. They include emollients, various keratolytics, or a combination, topical corticosteroids, pulsed-dye laser, and retinoids, both topical or systemic. 1217
A keratin plug fills the infundibulum of the hair follicle and protrudes above the surface for a variable distance (Fig. 15.24). Serial sections are sometimes necessary to show the plug to best advantage. A very sparse lymphocytic infiltrate may be present in the dermis adjacent to the follicular infundibulum. Mild telangiectasia and slightly more chronic inflammation may be seen in the rubra variant.
Keratosis pilaris. A keratin plug fills the infundibulum of the follicle and protrudes above the surface. (H & E)
The follicular keratoses that sometimes form at amputation sites are composed of large parakeratotic plugs. 1223
In keratosis follicularis squamosa (Dohi), a disorder of follicular keratinization reported from Japan, there is increased orthokeratin adjacent to the follicle, in addition to the follicular plug of keratin. 1227 Clinically, there are asymptomatic small scaly patches with a central follicular plug. 1227 It has been reported in association with pseudoacanthosis nigricans in an obese Japanese woman. 1228 This variant has been successfully treated with topical tacalcitol. 1229
The term ‘keratosis pilaris atrophicans’ refers to a group of three related disorders in which keratosis pilaris is associated with mild perifollicular inflammation and subsequent atrophy, particularly involving the face.1230. and 1231. Differences in the location and the degree of atrophy have been used to categorize these three conditions. Fortunately most cases cease to progress after puberty.
Treatment is usually unsuccessful. Emollients may be used. Antibiotics have no effect. Keratolytics and oral retinoids have also been used with mostly disappointing results. 1231
Keratosis pilaris atrophicans faciei is manifest soon after birth by follicular papules with an erythematous halo involving the lateral part of the eyebrows.1232. and 1233. It may later involve the forehead and cheeks. Pitted scars and alopecia usually result. 1233 Keratosis pilaris of the arms, buttocks, and thighs is often present. Less common clinical associations include atopy, mental retardation, 1233 woolly hair, 1234 cardiofaciocutaneous syndrome,1235. and 1236. Rubinstein–Taybi syndrome (OMIM 180849), 1237 Cornelia de Lange syndrome (OMIM 122470), 1238 Noonan’s syndrome (OMIM 163950),1239.1240.1241. and 1242. Bazex–Dupré–Christol syndrome (OMIM 301845), 1243 and a low serum vitamin A level. 1233 Some reports suggest an autosomal dominant inheritance. 1233 A gene in the 18p region may be involved. 1244
Keratosis follicularis spinulosa decalvans (OMIM 308800) is another exceedingly rare condition which begins in infancy with diffuse keratosis pilaris associated with scarring alopecia of the scalp and eyebrows.1245.1246.1247. and 1248. ‘Moth-eaten’ scarring of the cheeks usually results. Associations include atopy, acne keloidalis nuchae, 1249 photophobia, corneal abnormalities, Down syndrome, 1250 palmoplantar keratoderma, 1250 woolly hair, 1251 and other ectodermal defects. 1252 The gene maps to Xp21.1–p22.2. 1253 It is probably the SAT-1 gene which encodes spermidine/spermine NI-acetyltransferase. 1251 Females can be involved. 1254 Some cases are sporadic, while other cases appear to be autosomal dominant. 1255 On histological examination there is hyperkeratosis, follicular keratotic plugging, mild perifollicular chronic inflammation, and focal scarring. 1256 Biopsies from the scalp show a scarring alopecia with some features of folliculitis decalvans. 1257 A variant with autosomal dominant inheritance and inflammation that begins at puberty has been called ‘folliculitis spinulosa decalvans’. 1230
Treatment failure is the usual outcome. Oral isotretinoin is sometimes effective. 1249
Atrophoderma vermiculata (folliculitis ulerythematosa reticulata)1258. and 1259. involves the preauricular region and cheeks.1260.1261.1262.1263. and 1264. It may follow Blaschko’s lines. 1265 It develops in late childhood with the formation of horny follicular plugs which are later shed. This is followed by a reticulate atrophy with some comedones and scattered milia. Inheritance is autosomal dominant in type. Rare clinical associations include Marfan’s syndrome, 1266 leukokeratosis oris, 1267 and trichoepitheliomas with basal cell carcinomas (ROMBO syndrome – see p. 683).1268. and 1269. Keratosis pilaris of the limbs is quite commonly present. A condition described in the literature as atrophia maculosa varioliformis cutis (OMIM 601341) affects a similar location on the cheeks1270.1271.1272. and 1273. but there is no mention in these cases of a preceding stage with follicular plugging. 1270 Extrafacial involvement also occurs. 1274 Familial cases of this variant have been reported.1275. and 1276. It appears to be autosomal dominant. 1277 A disorder of elastin has been suggested. 1278 Another variant has been called ‘hereditary perioral pigmented follicular atrophoderma’ (OMIM 603587). It is associated with milia and epidermal cysts. 1279
All three conditions are regarded as congenital follicular dystrophies with abnormal keratinization of the superficial part of the follicles. A fourth condition, erythromelanosis follicularis faciei et colli, has minute follicular papules resulting from small keratin plugs associated with red-brown pigmentation and fine telangiectases.1280.1281.1282.1283.1284.1285.1286.1287. and 1288. Lesions are usually confined to the face and neck, but there may be extension onto the upper trunk. 1289 This rare disease appears to be another follicular dystrophy but is usually not considered with the other three conditions because it lacks any atrophy. Familial cases have been reported.1290.1291. and 1292. In one of these families keratosis pilaris was also present. 1291 It has also been present in many of the non-familial cases. 1289
In all three variants of keratosis pilaris atrophicans there is follicular hyperkeratosis with atrophy of the underlying follicle and sebaceous gland.1259.1293. and 1294. Comedones and milia may also be present. 1260 There is variable perifollicular fibrosis which may extend into the surrounding reticular dermis as horizontal lamellar fibrosis. 1245 The dermis may be reduced in thickness. A mild perivascular and perifollicular infiltrate of lymphocytes and histiocytes is usually present. In atrophia maculosa varioliformis cutis there is a thin epidermis, shallow epidermal depressions, and a slight dermal decrease or fragmentation in elastic fibers in the superficial and mid dermis. 1278
In erythromelanosis follicularis faciei et colli there is follicular hyperkeratosis, mild basal pigmentation, dilatation of vessels in the papillary dermis, and a reduction in size of the hair shafts and the inner and outer root sheaths. 1288
Lichen spinulosus is a rare dermatosis of unknown etiology characterized by follicular keratotic papules that are grouped into plaques, 2–6 cm in diameter. 1298 The horny spines protrude 1–2 mm above the surface. Lesions are distributed symmetrically on the extensor surfaces of the arms and legs and on the back, chest, face, and neck. Onset of the disease is in adolescence. It has been described in an HIV-positive man1299 and in an elderly female with Crohn’s disease. 1300 It is commonly seen in patients with an atopic diathesis.
Emollients and/or salicylic acid have been used successfully to treat this condition. 1301 The combination of tretinoin gel, 0.04%, applied nightly and hydroactive adhesive applications daily can also be used. 1301
In lichen spinulosus, there is a keratotic plug in the follicular infundibulum as in keratosis pilaris. However, there is a heavier perifollicular infiltrate of lymphocytes in lichen spinulosus, particularly adjacent to the infundibulum of the follicle, which is often dilated. Less constant changes include perifollicular fibrosis and atrophy of the sebaceous glands.
Lichen spinulosus is best regarded as a variant of keratosis pilaris in which the lesions are more papular, a consequence of the more pronounced dermal inflammation.
Pityriasis folliculorum is a neglected entity resulting from the presence of numerous mites of Demodex folliculorum in facial hair follicles. 1302 Clinically there are very small follicular scales that are dry, fine and pale giving a sandpaper-like texture to the skin. 1303 Mild erythema is present in the majority of cases. The scales correspond to the opisthosoma (caudal extremity) of the mites protruding through the follicular orifice.1302. and 1304. Mild hyperkeratosis is also seen on histology, but its contribution to the scale has not been assessed. 1303 There is often mild perifollicular chronic inflammation.
Rosacea (acne rosacea) is a fairly common disorder of adults, involving primarily the convexities of the central face (cheeks, chin, nose, and central forehead).1305.1306.1307.1308.1309.1310. and 1311. Rosacea may occur in other locations but the frequency and occurrence of this are ill-defined.1311. and 1312. Rarely, children are affected. 1313 It exists in five clinical forms,1311. and 1314. although cases with overlapping features are common:
1. an erythematous, telangiectatic type, accounting for 70% of cases1315
2. a papulopustular type
3. a granulomatous type (see p. 175)
4. a hyperplastic glandular type (phymatous rosacea) which results in irregular, bulbous enlargement of the nose, the condition known as rhinophyma1316
5. ocular disease.
Most cases are characterized by persistent erythema, recurrent episodes of flushing, edema, papules, and pustules. Later, telangiectasia, a burning sensation, and fibrosis occur. 1317 Central facial erythema from actinic damage should not be confused with rosacea. 1318 Ocular manifestations range from burning or itching to signs of conjunctival hyperemia, lid edema, rarely severe, 1319 and inflammation. 1311 Ocular involvement is sometimes quite severe in children. 1320 Rosacea in adults is more common in individuals who as children had an eyelid stye. 1321 It has been estimated by the National Rosacea Society in the United States that ‘14 million Americans’ have the disease. 1321
Rosacea has an equal sex incidence but the median age of presentation in males is about a decade later (59 years) compared to females (48 years). 1315 It has occurred in one of monozygotic twins. 1322 Severe rosacea developed for the first time in an elderly male coincident with the diagnosis of a recurrence of his colon cancer. 1323
Although the great majority of phymatous lesions occur on the nose (rhinophyma), they may also occur at other sites. Lesions involving lateral to the nasolabial fold, 1324 the chin (gnathophyma),1325. and 1326. and the ear (otophyma) have been reported. 1327 Rhinophyma has been reported in an adolescent male. 1328
Rosacea is a difficult entity to classify, not only because its pathogenesis is poorly understood but also because of the broad spectrum of histopathological changes found. 1329 Rosacea has been variously regarded as a folliculitis, a sebaceous gland disorder, a response to overabundant demodex mites, and a functional disorder of superficial dermal blood vessels associated with prominent flushing.1330. and 1331. The last of these possibilities is currently the most favored, although some of the evidence supporting it is somewhat circumstantial.1309.1332. and 1333. Vasodilator drugs may also exacerbate rosacea. 1334 Although there is enhanced skin blood flow in papulopustular rosacea, the increase is not significant in the erythemato-telangiectatic variant. 1335 Neoangiogenesis occurs in this latter variant. 1336 Lymphatics are increased in lesional skin from an early stage, even in the absence of edema. 1337 Demodex mites may be increased secondary to these vascular changes.1338. and 1339. Demodex mites have been regarded as a cofactor rather than the cause of rosacea, 1340 even though rosacea-like eruptions can be seen in response to heavy local infestations by Demodex folliculorum (rosacea-like demodicidosis – see p. 653).1302. and 1341. Recently, antigenic proteins from a bacterium, Bacillus oleronius, isolated from D. folliculorum in a patient with papulopustular rosacea, were found to have the potential to stimulate an inflammatory response in rosacea patients. 1342 Rosacea-like eruptions may also occur following the topical application of potent fluorinated steroids,1343.1344. and 1345. the use of a halogenated steroid nasal spray, 1346 and the application of pimecrolimus. 1347 A florid papulopustular eruption with a spiny filiform hyperkeratosis has developed during therapy with the multikinase inhibitor sorafenib. 1348 Acne rosacea has been reported in patients with HIV infection. 1349 There has been considerable interest in the role of Helicobacter pylori in the etiology of rosacea;1350.1351.1352.1353. and 1354. however, controlled trials offer no support for this association.1355.1356. and 1357. It is likely that the treatment used for H. pylori is beneficial for rosacea.1358.1359.1360.1361.1362. and 1363. A rosacea-like eruption has also occurred with Candida albicans infection. 1364
Perioral dermatitis (see p. 176) is possibly a related entity.1365.1366.1367.1368.1369. and 1370. It is characterized by burning, non-itchy, perioral erythema and papules usually associated with severe discomfort.1371. and 1372. It has been regarded by some as a subtype of rosacea in atopic patients. 1373 It may follow corticosteroid therapy. 1374Periocular dermatitis is considered to have a similar pathomechanism to perioral dermatitis. 1375 Sometimes rosacea will present with periorbital edema. 1376 This feature should not be confused with periocular dermatitis. Griffiths has drawn attention to a group of patients with lesions resembling what has been called perioral dermatitis which he calls the MARSH syndrome, combining as it does melasma, acne, rosacea, seborrheic eczema, and hirsutism. 1377
Attempts have been made to establish a global Rosacea Severity Index so that treatment outcomes can be standardized and compared.1378.1379. and 1380. In this regard, clinicians tend to focus on erythema, while patients focus on papules and pustules.
Topical metronidazole is well tolerated and efficacious for moderate to severe papulopustular rosacea. 1317 Maintenance therapy is usually continued to avoid recurrences on cessation of the drug. 1381 Trials have shown that topical azelaic acid is as effective as, or even better than, metronidazole.1382.1383. and 1384. Antibiotics have also been used. 1342 Azithromycin is at least as effective as a once daily, anti-inflammatory dose (40 mg) of minocycline.1385.1386. and 1387.
Pimecrolimus 1% cream is an effective and well-tolerated treatment for steroid-induced rosacea1388 and perioral dermatitis,1371. and 1389. even though tacrolimus and pimecrolimus may themselves produce a rosaceiform eruption.1347. and 1390. Nevertheless a randomized, double-blind study found that pimecrolimus was no more effective than treatment with the vehicle cream. 1391 This has been confirmed in another trial. 1392
Erythema and flushing have been controlled with oxymetazoline. 1393 Laser can be used to treat persistent telangiectasia. 1384 Intense pulsed light also reduces erythema and telangiectasia, and this is sustained for at least 6 months. 1394 Soap and rubbing with a cloth have been suggested as a means of reducing demodex mites. 1302 Photodynamic therapy was promising in one small case series. 1381 Isotretinoin is beneficial for mild to moderate rhinophyma but late stages require surgery. 1395
Rosacea is characterized by a combination of several histopathological features. Sometimes the histopathological changes are non-diagnostic. 1397 In the erythematous-telangiectatic group there is telangiectasia, sometimes prominent, of superficial dermal vessels (Fig. 15.25). There is a perivascular infiltrate of lymphocytes, usually mild to moderate in intensity. A small number of plasma cells are usually present and are an important clue to the diagnosis. Inconstant features include mild dermal edema, solar elastosis, and mild perifolliculitis. The papulopustular lesions have a more pronounced inflammatory cell infiltrate which is both perivascular and peripilar, involving the superficial and mid dermis. The infiltrate may include a few neutrophils as well as lymphocytes and plasma cells. Active pustular lesions show a superficial folliculitis while in older lesions a granulomatous perifolliculitis is often present. Keratotic follicular plugging, but not comedones, may be present. Demodex mites are present in 20–50% of cases. The granulomatous form1398 is usually characterized by a tuberculoid reaction, often in the vicinity of damaged hair follicles (see p. 175). Necrosis, resembling caseation, was present in 11% of patients in one series (Fig. 15.26). 1399
Rosacea. A perivascular and perifollicular infiltrate of lymphocytes and plasma cells is present. Several demodex mites are present in the hair follicle. (H & E)
Granulomatous rosacea. This florid case has extensive necrosis resembling caseation necrosis. (H & E)
Sebaceous gland hypertrophy and scattered follicular plugging are present in most cases of rhinophyma (Fig. 15.27). 1400 In the less common fibrous variant of rhinophyma, there is telangiectasia, diffuse dermal fibrosis with abundant mucin, a virtual absence of pilosebaceous structures, and an increase in factor XIIIa-positive cells in the dermis.1401. and 1402. Telangiectasia of superficial dermal vessels is also quite common, a feature which is not present in senile sebaceous gland hyperplasia. Demodex mites may be present in the pilosebaceous follicles. Inconstant features include solar elastosis, dilatation of follicles, focal folliculitis, and perifolliculitis. Sometimes, finger-like acanthotic downgrowths extend from the epidermis and follicular walls. 1400 The infiltrate of lymphocytes and plasma cells around superficial vessels varies from sparse to moderately heavy in intensity.
Rhinophyma. There is sebaceous gland hyperplasia in this shave biopsy. (H & E)
Direct immunofluorescence has demonstrated the presence of immunoglobulins and complement in the region of the dermoepidermal junction in some cases.1403. and 1404. Immunoperoxidase stains show increased expression of vascular endothelial growth factor (VEGF), CD31, and the lymphatic marker D2-40. 1337 Matrix metalloproteinase-9 (MMP-9) is increased in patients with rosacea and D. folliculorum mites, raising the possibility of a pathogenetic link. 1405
Pyoderma faciale is a rare disorder, now interpreted as a fulminant form of rosacea.1406.1407. and 1408. The term ‘rosacea fulminans’ has been suggested as a more appropriate designation. 1409 It is characterized by the sudden onset of confluent nodules and papulopustules on the face, in women who are usually in their twenties. 1406 Purulent material drains from many sinuses, which may be interconnecting. Pyoderma faciale may sometimes occur in association with inflammatory bowel disease1409.1410. and 1411. and erythema nodosum. 1412 Both commencement in pregnancy and postpartum onset have been reported.1413. and 1414. It has also occurred in a woman taking high-dose vitamin B supplements, cessation of which led to improvement. 1415
Conventional rosacea therapy is not effective. Short-term systemic corticosteroids usually followed by oral retinoids have been used. 1416 Topical corticosteroids are applied to lesional skin. Dapsone has been effective when this listed treatment failed. 1417
Few cases have been biopsied. There is usually a heavy dermal infiltrate of neutrophils, lymphocytes, and epithelioid cells with occasional granulomas with multinucleate giant cells. Perifollicular abscesses and sinus formation may be present.
The term ‘neutrophilic sebaceous adenitis’ has been used for the circinate plaques on the face of a teenage male which were characterized histologically by neutrophilic infiltration of the sebaceous glands. 1419 A case with similar clinical features, including spontaneous healing, has since been reported. 1420 It differed from the original case by having few neutrophils and many lymphocytes infiltrating sebaceous glands. This might have resulted from the age of the lesion, which had been present for 2 months at the time of the biopsy.
A sebotropic drug reaction has been reported following the ingestion of kava-kava extract, used as an antidepressant therapy. 1421 The extract contains kavapyrones which are lipophilic. A dense lymphocytic infiltrate disrupted sebaceous glands, which were partly necrotic. 1421
A sebaceous adenitis (sebaceitis) can also be seen in herpes folliculitis.
Multiple spiky lesions have been reported in the nasolabial region following isotretinoin therapy for acne. Microscopy revealed cast-like accumulations of holocrine secretion, derived from sebaceous glands (sebaceous casts), on the surface of the stratum corneum. 1422 Subsequent correspondence suggested that this change had been reported earlier as follicular filaments (follicular casts). 1423
Apocrine glands are found regularly in the axilla, anogenital region, the areola and nipple of the female breast, the eyelids (Moll’s glands), and the external auditory canal. They are sometimes found in the skin of the scalp and the face. Apocrine glands are derived from the primary epithelial germ along with the hair follicle and sebaceous gland.
The apocrine gland consists of a secretory portion in the deep dermis or subcutis and a short duct which enters into the infundibulum of the hair follicle, above the entry of the sebaceous duct. Apocrine glands have a variable appearance in tissue sections, reflecting the functional state of the gland; secretions are stored in the gland. Both a ‘budding type’ (apocrine secretion) and a merocrine type of cytoplasmic secretion occur.
A recent detailed study of axillary skin failed to detect any glands resembling the apoeccrine gland. 1424 This has pathogenetic implications for axillary hyperhidrosis, as the higher output of these glands has been presumed to be of importance in hyperhidrosis. 1424